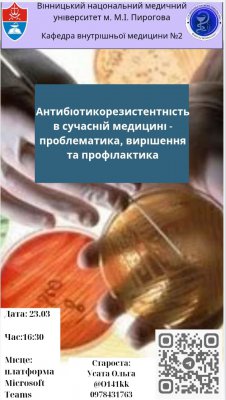

Студенту
Інтерну
Master
Аспіранту
Слухачу
Силабус
Вибіркові курси
Кваліфікаційні роботи
Clinical ordinator
Історія кафедри
ОСНОВНІ ЕТАПИ ДІЯЛЬНОСТІ
КАФЕДРИ ВНУТРІШНЬОЇ МЕДИЦИНИ № 2
Кафедра заснована в серпні 1936 року. Першими викладачами були професор Е.Я. Фішензон, професор М.М. Гефт, асистенти М.Ф. Шинкарьова, С.Д. Заславська. До Другої світової війни колектив кафедри працював над проблемою діагностики та лікування захворювань серцево-судинної системи та шлунково-кишкового тракту.
В післявоєнні роки кафедру очолив професор Я.М. Бритван, потім Г.Д. Давидов та доцент Б.І. Лідський. У цей період наукова тематика кафедри була пов'язана з вивченням патології серцево-судинної системи та захворювань системи крові (асистенти І.А. Рибачук, В.Д. Пилат та ін.). Вийшла з друку монографія доц. Б.І. Лідського "Практическое пособие по лекарственной терапии внутренних болезней", в якій висвітлені основні аспекти фармакодинаміки різних лікарських препаратів та викладені рекомендації щодо їх використання в практичній медицині.
З 1952 до 1956 року кафедрою завідував професор Ф.Ф.Піайд. Під його керівництвом вивчалися питання онкології, були виконані кандидатські дисертації асистентами Т.П. Чуберкіс та О.М. Кучеренко.
В 1956 році колектив кафедри очолила професор Н.Н. Колотова. Наукові інтереси кафедри в цей час були пов'язані з вивченням захворювань системи крові. Внаслідок наукових пошуків вийшла друком монографія проф. Н.Н. Колотової "Полицитемия", захищена кандидатська дисертація В.М. Войтюк, надруковано 48 наукових статей.
У 1961 році завідувачем кафедрою призначається доцент Ю.М. Головцев. Співробітниками кафедри вивчаються питання гемодинаміки при гіпотоніях (доц. М.Б. Шкляр), деякі аспекти гепатології, обміну мікроелементів при атеросклерозі (доц. Ю.М. Головцев). Захищені кандидатські дисертації асистентами Г.І. Романовим, Г.М. Альохіним, Л.І.Кошевською.
З 1967 року кафедрою завідував професор О.П. Кучук. У цей час до складу кафедри входило декілька доцентських курсів, зокрема, доцентський курс з фтизіатрії, який очолював доц. Б.А. Березовський; доцентський курс з ендокринології на чолі з доцентом Б.О. Зелінським та доцентський курс з лікувальної фізкультури на чолі з доцентом Л.В. Малишевою.
На кафедрі навчалися студенти V та VI курсів лікувального факультету. В 1974 році доцентський курс з фтизіатрії був реорганізований в окрему кафедру (зав. - професор Б.А. Березовський), а в 1973 році кафедра госпітальної терапії була поділена на дві кафедри - госпітальної терапії 1 (зав. - професор О.П. Кучук) та госпітальної терапії 2 (зав. - професор Б.О. Зелінський); в 1983 році доцентський курс з лікувальної фізкультури був переведений на кафедру фізкультури.
Відповідно до програми вузу з госпітальної терапії на кафедрі здійснюється поглиблене вивчення захворювань внутрішніх органів, диференційної діагностики хвороб серця, легенів, шлунково-кишкового тракту, нирок, професійної патології, захворювань системи крові, військово-польової терапії. Найбільш досвідчені викладачі (професори, доценти) здійснюють підготовку студентів-субординаторів на VI курсі. В останні роки перевага в підготовці субординаторів віддається цикловій системі (цикли з кардіології, пульмонології, гастроентерології та ін.). Співробітниками кафедри публікується ряд методичних матеріалів стосовно особливостей вивчення пульмонології (О.П. Кучук, Т.М. Липницький, О.О. Яковлєва), а також з питань вдосконалення навчального процесу (В.П. Маленький, Т.П. Чуберкіс, Г.Д. Симбірцева, О.О. Яковлєва, Ю.К. Откаленко, В.П. Довгаленко). Вийшли з друку методичні матеріали: "Методические указания для студентов VI курса к практическим занятиям по неотложной помощи и интенсивной терапии при некоторых ургентных состояниях в клинике внутренних болезней".

На фото: Професор КучукА.П., асистент Остафійчук О.К.,завідуюча терапевтичним відділенням Чикановська В.М.
Відповідний внесок кафедра вносить в підготовку лікарів-інтернів: готуються методичні матеріали, читаються цикли лекцій, проводяться заняття з керівниками інтернів, здійснюється контроль підготовки інтернів на базах Вінницької та Житомирської областей (проф. О.П. Кучук, проф. В.П. Маленький, доц. Т.П. Чуберкіс). Виходять з друку декілька методичних рекомендацій для лікарів-інтернів та їх керівників: "Пути со-вершенствования клинического мышления в интернатуре по терапии", "Работа врачей-интернов терапевтического профиля в поликлинике". "Методика расшифровки КГ", "Дифференциальная диагностика бронхо-обструктивного синдрома".
Співробітниками кафедри вивчались проблеми пульмонології, гастроентерології та профпатології. Тільки за останні роки на основі наукових досліджень було захищено три докторські дисертації: В.П. Маленьким: "Епідеміологія, клініка, діагностика, лікування і профілактика хронічного бронхіту у механізаторів сільського господарства"; В.М. Чорнобровим: "Шляхи поліпшення діагностики і лікування виразкової хвороби і хронічного гастриту (досягнення та перспективи внутрішньо-шлункової рН-метрії)"; О.О. Яковлєвою: "Диференційна діагностика ліпідного гемостазу у хворих неспецифічними захворюваннями легенів та обгрунтування метаболічної корекції вітамінами А та В".
Виходять з друку методичні рекомендації: „Техника и методика усовершенствования внутриполостной рН-метрии верхнего отдела же-лудочно-кишечного тракта", "Клиническое применение индикатора кислотности желудка" (В.М. Чорнобровий, Н.А. Півторак), "Способы диагностики метаболической функции легких и возможности ее кор-рекции" (О.О. Яковлева), інформаційні листки за матеріалами досліджень. Удосконалюються техніка та методи внутрішньо-шлункової рН-метрії (В.М. Чорнобровий), на основі яких конструкторське бюро медичної електротехніки (м. Кам’янець-Подільський) здійснює серійний випуск індикаторів кислотності шлунка. Отримано 8 авторських свідоцтв на винаходи (автори - проф. В.П. Маленький, В.М. Чорнобровий, доц. Ю.К. Откаленко). За період з 1967 до 1992 року на кафедрі захищено 8 докторських дисертацій (Б.А. Березовський, Б.О. Зелінський, О.М. Кучеренко, Б.З. Сухоруков, В.П. Маленький, В.М. Чорнобровий, М.Б. Шкляр, О.О. Яковлєва) та 13 кандидатських дисертацій (Н.С. Жук, Г.А. Новицький, Л.Ф. Проценко, В.А. Віктора, А.Х. Бровко, Г.А. Потолочна, О.С. Когут, О.О. Яковлева, Л.В. Юдіна, Г.О. Шокур, Л.В. Черешнюк, О.К. Остафійчук, О.Г. Шанчук).

На фото: Доцент Маленький В.П з лікарями-інтернами
В 1992 році кафедру очолив професор В.П. Маленький. На цей час на кафедрі працює три професори (В.П. Маленький, О.П. Кучук, В.М. Чорнобровий), сім доцентів (О.Г. Шанчук, Т.П. Чуберкіс, Г.Д. Симбірцева, М.С. Атаманчук, Ю.К. Откаленко, І.І. Дорошенко, В.П. Довгаленко), асистенти О.І. Наливайко, В.М. Шеверда, С.Г. Самохвал, Н.П. Масик, Н.А. Півторак. У складі кафедри є доцентський курс з гематології, який очолює доцент Г.Д. Симбірцева.


На фото: клінічна база кафедри МКЛ № 2 (на даний час МКЛ ШМД)
Клінічною базою кафедри є терапевтичне відділення на 70 ліжок, пульмонологічне відділення на 60 ліжок на базі 2-ої міської клінічної лікарні, гастроентерологічне та терапевтичне відділення відповідно на 40 та 60 ліжок 1-ої міської клінічної лікарні. Крім того, заняття з невідкладної кардіології для студентів VI курсу проводяться у відділенні гострої коронарної недостатності на 40 ліжок 4-ої міської клінічної лікарні. Курс гематології викладається на базі гематологічного відділення обласної лікарні ім. М.І. Пирогова.
На початку 90-х років на кафедрі проведена велика робота з комп'ютеризації навчального процесу. Навчально-діагностичний кабінет, створений на кафедрі, укомплектований сучасними персональними комп'ютерами типу ІВМ.
Силами співробітників кафедри відпрацьовані тести у відповідності до програми з госпітальної терапії, створені на їх базі навчально-контролюючі програми, ситуаційні задачі. Видано два навчально-методичних посібники:"Программированньій тестовьій контроль знаний студентов по госпитальной терапии" (під ред. проф. В.П. Маленького); "Навчально-методичний посібник для самостійної підготовки студентів до практичних занять з госпітальної терапії" (ред. - проф. В.П. Маленький). Підготовлено до друку ще два навчальні посібники - навчальний посібник з набором ситуаційних задач та ЕКГ, рішення яких буде здійснюватися за допомогою ЕОМ.
В 1992-1993 навчальному році на кафедрі було вперше проведено двоступеневий перевідний іспит з терапії з тестуванням на комп'ютері. З урахуванням оснащеності кафедри комп'ютерною технікою та досвіду програмного забезпечення навчального процесу в 1993 році на її базі були проведені семінари завідуючих навчальними частинами кафедр клінічного та теоретичного профілів.
Основними напрямками наукових досліджень співробітників кафедри, як і раніше, є проблеми пульмонології та гастроентерології.
Зокрема, проводяться пошуки з застосування ентеросорбента полісорбу при лікуванні хворих гострими та хронічними запальними процесами бронхо-легеневої системи і органів травлення. За цією тематикою виконуються дві госпдоговірні теми, три кандидатські дисертації. Захищена кандидатська дисертація асистента Н.А. Півторак на тему: "Критерії доклінічної діагностики і особливості амбулаторного лікування загострень виразкової хвороби дванадцятипалої кишки".
За результатами наукових досліджень за останні три роки опубліковано 56 праць. При активній участі проф. В.М. Чорнобрового проведена І Подільська науково-практична конференція гастроентерологів.
На кафедрі здійснюється клінічна оцінка нової медичної техніки для спелео- та фітотерапії згідно з угодою про наукове співробітництво між інститутом та науково-виробничою фірмою "Медприбор".
Значно поліпшилася діагностична і лікувальна база кафедри. В цей час впроваджено ендоскопічне обстеження хворих за допомогою апаратів японської фірми "Олімпус", яку кафедра отримала, дякуючи допомозі спонсорів; у відділенні пульмонології обладнано кімнату для спелеотерапії, фітобар; у терапевтичному відділенні - кабінет лазеротерапії.
В цей час на кафедрі проходили підготовку два клінічних ординатори: О.М. Шанчук, С.Г. Мелащенко та магістрант Т.П. Пасека, які успішно поєднують навчання з науковими дослідженнями. Щорічно на наукових конференціях гуртківці кафедри посідали призові місця. В 1992 році студент VI курсу В.Ф. Кривецький став переможцем Всеукраїнської олімпіади з терапії та був нагороджений дипломом.
Велику допомогу співробітники кафедри надають лікарям практичної охорони здоров'я: проводять навчання лікарів-фахівців на тематичних циклах удосконалення з інтрагастральної рН-метрії (проф. В.М. Чорнобровий), читають цикли лекцій з актуальних проблем медицини. Щорічно професорами та доцентами консультуються біля З тисяч хворих у відділеннях та поліклініці, організовуються виставки нової діагностичної техніки для дослідження функції шлунка, впроваджуються нові методи дослідження функціонального стану органів дихання, лабораторні методи діагностики запальних процесів.
Професор В.М. Чорнобровий із співробітниками створюють окрему кафедру поліклінічної терапії та сімейної медицини.
Творча енергія співробітників кафедри спрямована на подальше поліпшення підготовки фахівців, що планується реалізувати через удосконалення методичного забезпечення навчального процесу, подальшу його комп'ютеризацію, підвищення педагогічної майстерності викладачів, поліпшення матеріальної бази кафедри, інтенсифікацію наукових пошуків.
Того часу на кафедрі виконано 1 докторську дисертацію (доц. Колісник П.Ф.), 5 кандидатських робіт (Масік Н.П., Нечипорук С.В., Шанчук О.М., Корнєєв Б.І., Лисенко Д.А.). Виконується 2 докторських дисертації (к. мед. наук Солєйко О.В., к. мед. наук Лисенко Д.А.) та 6 кандидатських дисертації: ас. Данченко Л.П., ас. Коробко О.А., ас. Бондарчук С.В., старший лаборант, аспірант Гуменюк І.П., старший лаборант, аспірант Ільюк І.А., аспірант Чорноброва О.І.
Останнє десятиріччя ознаменувалося тим, що в роботі кафедри було взято курс на вдосконалення педагогічного процесу, інтенсифікацію наукових досліджень, видавничої діяльності, підвищення якості допомоги органам охорони здоров’я.
Для реалізації намічених планів 11 квітня 2000 року за ініціативи та при безпосередній участі кафедри госпітальної терапії №1 було проведено всеукраїнську науково-практичну конференцію «Невідкладні стани в медицині», яка присвячувалась ювілею 2-ої міської лікарні м. Вінниці – базової клініки кафедри госпітальної терапії. За матеріалами конференції професором Маленьким В.П. підготовлено до друку і видано книгу «Невідкладні стани в медицині», яка затверджена методичним кабінетом з вищої освіти МОЗ України в якості посібника для студентів вищих навчальних закладів III – ІV рівнів акредитації. Враховуючи побажання лікарів-практиків, багато чисельні запити студентів старших курсів, готовиться до друку друге, перероблене і значно доповнене видання цієї книги.
З метою підготовки студентів 5-го курсу до ліцензійного іспиту з внутрішніх хвороб, який вони складають на 6-му курсі та адаптацію їх до нової форми державного іспиту (практично-орієнтований іспит), завідуючим кафедрою професором Маленьким В.П. за активної участі співробітників кафедри підготовлено до друку і видано в 2002 році навчальний посібник «Терапія в тестах», куди включено програмні тести з терапії та професійних хвороб. Посібник рекомендований до друку методичним кабінетом з вищої освіти МОЗ України в якості посібника для студентів вищих навчальних закладів III – ІV рівнів акредитації. Для роботи з тестами співробітниками кафедри створена відповідна комп’ютерна програма. За допомогою цієї програми на кафедрі визначається рівень підготовки студентів по кожному розділу програми, проводиться передекзаменаційне тестування, яке являється обов’язковим елементом трьохкомпонентної системи іспитів з терапії (практичні навички, комп’ютерне тестування, усний іспит по білету). Передбачається часткове оновлення тестів кожні 2-3 роки.
Завідувачем кафедри професором Маленьким В.П. підготовлено до друку і видано у видавництві «Нова книга» підручник «Професійні хвороби», який рекомендовано до друку МОЗ України.


За останні роки співробітниками кафедри було виконано 2 планові науково-дослідні роботи: «Вивчити ефективність ентеросорбції з використанням полісорбу ММ (Силіксу) у хворих на обструктивні захворювання легень» (закінчена в 1998 році з захистом кандидатської дисертації Масік Н.П.); «Вивчити клінічну ефективність комплексного лікування хворих на хронічний бронхіт з супутнім дисбактеріозом кишечнику з використанням ентеросорбції препаратами силіксу та розробити і впровадити в практику схему лікування» (закінчена в 2004 році).
Співробітниками кафедри виконуються наукові роботи, які привертають увагу міжнародної спільноти. Так робота Маленького В.П., Ільюк І.А. по застосуванню тіотриазоліну при лікуванні пневмоній отримала бронзовий грант на конференції ERS в Копенгагені (2005 рік), та срібний грант на конференції ERS в Мюнхені (2006 рік).
Кафедра госпітальної терапії №1 активно співпрацює з деякими науково-дослідними інститутами АМН України. Зокрема з інститутом гематології та трансфузіології, налагоджується також співробітництво з інститутом геронтології АМН України. Як наслідок такої співпраці, видано клінічні лекції з гематології, співавторами яких є співробітники кафедри асистенти Лисенко Д.А., Бондарчук С.В., захист кандидатської дисертації з гематології Лисенком Д.А. і успішна робота над докторської дисертацією, виконання кандидатської дисертації з гематології аспіранткою Чорнобровою О.І.
Кафедра госпітальної терапії №1 була перейменована на кафедру внутрішньої медицини №2 у зв’язку з введенням Болонської програми навчання. Творча енергія співробітників кафедри спрямована на подальше поліпшення підготовки фахівців, що планується реалізувати через удосконалення методичного забезпечення навчального процесу, подальшу його комп'ютеризацію, підвищення педагогічної майстерності викладачів, поліпшення матеріальної бази кафедри, інтенсифікацію наукових пошуків.
За останні роки на кафедрі виконано 2 докторські дисертації (доц. Колісник П.Ф., доц. Солєйко О.В.), 9 кандидатських робіт (Масік Н.П., Нечипорук С.В., Шанчук О.М., Корнєєв Б.І., Лисенко Д.А., Коробко О.А., Гуменюк І.П., Ільюк І.А., Кравець Р.А.). Виконується 2 докторські дисертації (доц. Лисенко Д.А., доц. Масік Н.П.) та 3 кандидатських дисертації: ас. Данченко Л.П., ас. Бондарчук С.В., Осипенко І.П.
В 2008 році кафедру очолив д.мед.н., професор Колісник П.Ф. Під керівництвом д.мед.н. Колісника П.Ф. була проведена науково-дослідна робота кафедри «Особливості лікувально-реабілітаційних заходів при захворюваннях внутрішніх органів і систем у пацієнтів з супутньою патологією хребта». В рамках цієї роботи було захищено три кандидатські дисертації: Хомовський В.В., Гуменюк І.П., Кравець Р.А.

З 2013 року посаду завідувача кафедри займає д.мед.н., професор Шевчук Сергій Вікторович.

З 2013 р. кафедра є базою Фармакологічного комітету України з випробувань нових лікарських препаратів. Кафедра бере участь в проведенні міжнародних рандомізованих контрольованих клінічних досліджень, співпрацює з іншими науковими закладами - Інститутом кардіології ім. М.Д. Стражеска, Українським НДІ реабілітації інвалідів та іншими кафедрами університету. У 2015 р. успішно завершена науково-дослідна робота кафедри «Вивчення закономірностей формування серцево-судинних уражень у хворих на антифосфоліпідний синдром та розробити диференційовані підходи до їх фармакологічної корекції», за результатами якої видано 14 інформаційних листів (проф. Шевчук С.В., ас. Куриленко І.В., ас. Сегеда Ю.С.), отримано 20 патентів на корисну модель. 2016-2019 рр. під керівництвом проф. Шевчука С.В. виконувалась фундаментальна НДР «Вивчити роль клінічних, молекулярно-генетичних, метаболічних, імунозапальних та гемокоагуляційних чинників у формуванні серцево-судинних уражень при ревматоїдному артриті та розробити рекомендації з їх профілактики та лікування», 2019 - 2022 рр. - "Вивчити клінічні, метаболічні, генетичні та імунозапальні чинники розвитку остеопорозу та саркопенії у хворих на системний червоний вовчак", 2022-2024 рр. - "Генетичні та середовищні чинники остеопорозу та його ускладнень при ревматичних захворюваннях". Під керівництвом проф. Шевчука С.В. успішно захищені кандидатські дисертації Куриленко І.В., Сегеди Ю.С., Кувікової І.П., Денищич Л.П., Звягіної О.В., Сторожука О.Б., Павлюк О.М. На разі виконуються ще 3 дисертації на здобуття ступеню вищої освіти доктора філософії: Степанюк Т.В., Мальованої Т.С., Побережець А.О.
Керівництво гуртка
Студентський науковий гурток кафедри внутрішньої медицини №2 2025-2026 навч.рік
Куратор: асистент ЗВО Світлана БОНДАРЧУК, тел +380676657080,svitvitbond@ukr.net
Староста гуртка у І семестрі 2025-2026 навч. року: Тросцінський Ярослав, студент 6курсу, 1а групи, +380732306352, s009989@vnmu.edu.ua
Староста гуртка у ІІ семестрі 2025-2026 навч. року: Усата Ольга Андріївна, студентка4 курсу, 6а групи, тел. +380978431763, usataolga2007@gmail.com
Оголошення про засідання гуртка надаються на сайт кафедри внутрішньої медицини№2, сайт СНТ ВНМУ ім. М.І. Пирогова, у телеграм-чаті гуртка:https://t.me/+MzQAb1GtWAhiYzli.
Засідання гуртка проводяться регулярно 2 рази/місяць у понеділок або четвер о16.30.
Місце і формат проведення залежить від теми, задіяних ресурсів,епідеміологічної та військово-енергетичної ситуації:Кафедра внутрішньої медицини №2, м. Вінниця, Хмельницьке шосе, 104,Гематологічне відділення КНТ «ВОКЛ імені М.І.Пирогова ВОР» м.Вінниця, вул.Пирогова, 46 Симуляційний центр ВНМУ імені М.І.Пирогова
Сумісне засідання з кафедрою інфекційних хвороб та кафедрою ендокринології уморфологічному корпусі , аудиторії №5Он-лайн у Mscrosoft Teams:https://teams.microsoft.com/l/team/19%3AEgMowWmWgUS9NY7gZKlaT3yjyWs7BW5Fg21IepynHmI1%40thread.tacv2/conversations?groupId=8caed205-77d9-4472-a6a5-9007aa5667ff&tenantId=7346d930-ca22-4336-8ec1-7d11541393e4
Тематичний план засідань гуртка
План роботи СНГ “Внутрішня медицина №2”
на осінний семестр 2025-2026 н.р.
|
№ з/п |
Тема |
Дата проведення |
Відповідальний |
Відмітка про виконання |
|
1 |
Професійні захворювання різних професій |
19.09.2025 |
8б V курс, 1 а VІ курс, ас. ЗВО Бондарчук С.В., ас. ЗВО Мальована Т.С. |
Виконано |
|
2 |
Вади розвитку серця та судин |
29.09.2025 |
11а V курс, доц. ЗВО Денищич Л.П. |
Виконано |
|
3 |
Міждисциплінарна сесія CCD |
13.10.2025 |
ІV, V, VІ курс, ас.ЗВО Бондарчук С.В. |
Виконано |
|
4 |
Актуальні питання внутрішньої медицини |
22.10.2025 |
6б V курс,1а VІ курс, доц.ЗВО Маринич Л.І. |
Виконано |
|
5 |
Психічні розлади у структурі професійної захворюванності |
13.11.2025 |
6б,7б,8б V курс, 3с VІ курс, ас. ЗВО Бондарчук С.В. |
Виконано |
|
6 |
Захворювання міокарда |
04.12.2025 |
6б,8б V курс, доц.ЗВО Маринич Л.І. |
Виконано |
План роботи СНГ “Внутрішня медицина №2”
на весняний семестр 2025-2026 н.р.
|
№ з/п |
Тема |
Дата проведення |
Відповідальний |
Відмітка про виконання |
|
1 |
Професійні інфекційні захворювання медиків |
12.02.2026 |
7а, V курс, ас. ЗВО Бондарчук С.В. |
|
|
2 |
Нові технології у визначення прогнозу перебігу ХОЗЛ |
26.02.2026 |
7б ІV курс, доц. ЗВО Ільюк І.А. |
|
|
3 |
Особливості організації військової медичної допомоги в Україні |
12.03.2026 |
12б, V курс, ас. ЗВО Бондарчук С.В. |
|
|
4 |
Антибіотикорезистентність в сучасній медицині |
26.03.2026 |
12б, ІV курс, доц. ЗВО Ільюк І.А. |
|
|
5 |
Міждисциплінарна сесія CCD |
09.04.2026 |
ІV, V, VІ курс, ас. ЗВО Бондарчук С.В. |
|
|
6 |
Актуальні питання внутрішньої медицини |
23.04.2026 |
8б ІV курс, доц.ЗВО Ільюк І.А. |
|
|
7 |
Актуальні питання гематології |
07.05.2026 |
6а,7а,8а V курс, ас. ЗВО Бондарчук С.В. |
Звіти засідань гуртка
Протокол засідання студентського наукового гуртка кафедри внутріншьої медицини №2 ВНМУ ім. М. І. Пирогова
Гурток з професійних хвороб.
за І півріччя _2024-2025_ н.р.
|
Дата |
Доповідач |
Група |
Курс |
Факультет |
Тема доповіді |
Загальна кількість присутніх на гуртку |
|
|
07.10.2024
|
Кондор Веніамін Іванович |
9-а |
5 |
МЕДИЧНИЙ 1 |
“Вібраційна хвороба” |
10 |
|
|
Горбенко Ольга Володимирівна |
9-а |
5 |
МЕДИЧНИЙ 1 |
''Хвороби функціонального перенапруження'' |
|||
|
Тросцінський Ярослав Йосипович |
9-а |
5 |
МЕДИЧНИЙ 1 |
''Хвороби функціонального перенапруження'' |
|||
|
Вербіцька Аріана Юріївна |
9-а |
5 |
МЕДИЧНИЙ 1 |
''Металева лихоманка'' |
|||
|
Годлевська Валерія Русланівна |
9-а |
5 |
МЕДИЧНИЙ 1 |
''Металева лихоманка'' |
|||
|
21.10.24 |
Федорович Юлія Максимівна |
7-а |
5 |
МЕДИЧНИЙ 1 |
``Covid-19 як професійне захворювання'' |
11 |
|
|
Дата |
Доповідач |
Група |
Курс |
Факультет |
Тема доповіді |
Загальна кількість присутніх на гуртку |
|
21.10.24 |
Мартинюк Дарʼя Павлівна |
7-а |
5 |
МЕДИЧНИЙ 1 |
``Covid-19 як професійне захворювання'' |
|
|
|
Загребельна Анна Ігорівна |
7-а |
5 |
МЕДИЧНИЙ 1 |
''Шкідливі та небезпечні чинники виробничого середовища медичних працівників’’ |
|
|
|
Жмур Андрій Андрійович
|
7-а |
5 |
МЕДИЧНИЙ 1 |
''Шкідливі та небезпечні чинники виробничого середовища медичних працівників’’ |
11 |
|
|
Мельничук Поліна Сергіївна |
9-а |
5 |
МЕДИЧНИЙ 1 |
''Професійний гепатит С'' |
|
|
|
Ткачук Віталія Віталіївна |
9-б |
4 |
МЕДИЧНИЙ 1 |
''ПРОФЕСІЙНІ ХВОРОБИ ЛІКАРІВ-ОФТАЛЬМОЛОГІВ'' |
8 |
|
04.11.24 |
Сікорський Микола Валерійович |
9-б |
5 |
МЕДИЧНИЙ 1 |
''Професійні хвороби медиків. Туберкульоз'' |
|
|
|
Музиченко Андрій Романович |
10-a |
5 |
МЕДИЧНИЙ 1 |
‘’Професійні захворювання в практиці лікаря-отоларинголога’’ |
|
|
04.11.24 |
Зелінський Юрій Олегович |
10-а |
5 |
МЕДИЧНИЙ 1 |
‘’Професійні захворювання в практиці лікаря-отоларинголога’’ |
|
|
|
Чорній Евеліна Олегівна |
9-а |
5 |
МЕДИЧНИЙ 1 |
''Професійні захворювання анастезіологів ''
|
8 |
|
|
Шкондін Станіслав Віталійович |
8-а |
5 |
МЕДИЧНИЙ 1 |
''Синдром нічного апное сну як професійна патологія'' |
|
|
18.11.24 |
Степанець Катерина Павлівна |
6-б |
5 |
МЕДИЧНИЙ 1 |
''Професійні хвороби органів дихання токсико-хімічної етіології'' |
|
|
|
Руденок Анна Юріївна |
27-б |
4 |
МЕДИЧНИЙ 1 |
''Азбестоз'' |
|
|
|
Сирота Марія Геннадіївна |
8-а |
5 |
МЕДИЧНИЙ 1 |
''Пестициди: балансування між потребами сільського господарства та здоров'ям людини.Альтернативи їх використання'' |
|
|
|
Гаркуша Віталіна Василівна |
8-а |
5 |
МЕДИЧНИЙ 1 |
''Пестициди: балансування між потребами сільського господарства та здоров'ям людини.Альтернативи їх використання.'' |
|
Звіт про роботу студентського наукового гуртка кафедри внутрішньої медицини №2 ВНМУ ім. М. І. Пирогова
Гурток внутрішньої медицини№2
за II півріччя 2024-2025 н.р.
|
Дата проведення засідання |
Доповідач |
Група |
Курс |
Форма навчання (бюджет/контракт) |
Факультет |
Тема доповіді |
Загальна кількість присутніх на гуртку |
|
19/02/2025 |
Сазонова Софія Олександрівна |
6-б |
5 |
бюджет |
МЕДИЧНИЙ 1 |
«.Перспективи та проблеми практичного використання стовбурових клітин» |
10 |
|
Шилова Софія Сергіївна |
6-Б |
5 |
бюджет |
МЕДИЧНИЙ 1 |
«Перспективи та проблеми практичного використання стовбурових клітин» |
||
|
|
Степанець Катерина Павлівна |
6-Б |
5 |
бюджет |
МЕДИЧНИЙ 1 |
``Середземноморська лихоманка`` |
|
|
|
Павлова Аліна Вікторівна |
6-Б |
5 |
бюджет |
МЕДИЧНИЙ 1 |
``Середземноморська лихоманка`` |
|
|
|
Ольховик Євгеній Володимирович |
6-Б |
5 |
бюджет |
МЕДИЧНИЙ 1 |
``Хвороба Стілла у дорослих`` |
|
|
|
Хмільова Анастасія Дмитрівна |
6-Б |
5 |
бюджет |
МЕДИЧНИЙ 1 |
''Вагітність та ревматичні захворювання'' |
|
|
Дата проведення засідання |
Доповідач |
Група |
Курс |
Форма навчання (бюджет/контракт) |
Факультет |
Тема доповіді |
Загальна кількість присутніх на гуртку |
|
|
Горбенко Ольга Володимирівна |
9-а |
5 |
бюджет |
МЕДИЧНИЙ 1 |
’’Синдром сухого ока в IT-спеціалістів'' |
|
|
|
Тросцінський Ярослав Йосипович |
9-а |
5 |
бюджет |
МЕДИЧНИЙ 1 |
|
8 |
|
20.02.25 |
Дунаєва Ірина Віталіївна |
14-а |
5 |
бюджет |
МЕДИЧНИЙ 1 |
’’ Синдром зап'ястного каналу у програмістів та офісних працівників’’ |
|
|
|
Турупалов Руслан Юрійович |
5-б |
5 |
бюджет |
МЕДИЧНИЙ 1 |
'’Професії майбутнього та пов’язані з ними професійні хвороби’’ |
|
|
|
Харченко Владислав Володимирович |
5-б |
5 |
бюджет |
МЕДИЧНИЙ 1 |
|
|
|
Дата |
Доповідач |
Група |
Курс |
Форма навчання |
Факультет |
Тема доповіді |
Загальна кількість присутніх на гуртку |
|
|
Чорній Евеліна Олегівна |
9-а |
5 |
Бюджет |
МЕДИЧНИЙ 1 |
|
|
|
|
Горбенко Ольга Володимирівна |
9-а |
5 |
Бюджет |
МЕДИЧНИЙ 1 |
‘’ЗДА при ГЕРХ’’ |
|
|
05.03.25 |
Вербіцька Аріана Юріївна |
9-а |
5 |
Бюджет |
МЕДИЧНИЙ 1 |
Від дзеркала до тарілки:РХП, причини, види та лікування |
10 |
|
|
Годлевська Валерія Русланівна |
9-а |
5 |
Бюджет |
МЕДИЧНИЙ 1 |
|
|
|
|
Тросцінський Ярослав Йосипович |
9-а |
5 |
Бюджет |
МЕДИЧНИЙ 1 |
’’Остеопороз’’ |
|
|
|
Кондор Веніамін Іванович |
9-а |
5 |
Бюджет |
МЕДИЧНИЙ 1 |
|
|
|
|
Мельничук Поліна Сергіївна |
9-а |
5 |
Бюджет |
МЕДИЧНИЙ 1 |
‘’Вплив соціальних мереж на розвиток РХП’’ |
|
|
|
Пруба Роман Романович |
9-а |
5 |
Бюджет |
МЕДИЧНИЙ 1 |
’’Дієта після баріатричної операції’’ |
|
Оголошення гуртка
Оголошення про засідання гуртка надаються на сайт кафедри внутрішньої медицини№2 в рубриці "Новини", сайт СНТ ВНМУ ім. М.І. Пирогова, у телеграм-чаті гуртка:https://t.me/+MzQAb1GtWAhiYzli.
Засідання гуртка проводяться регулярно 2 рази/місяць у понеділок або четвер о16.30.
Місце і формат проведення залежить від теми, задіяних ресурсів,епідеміологічної та військово-енергетичної ситуації:Кафедра внутрішньої медицини №2, м. Вінниця, Хмельницьке шосе, 104,Гематологічне відділення КНТ «ВОКЛ імені М.І.Пирогова ВОР» м.Вінниця, вул.Пирогова, 46 Симуляційний центр ВНМУ імені М.І.Пирогова
Сумісне засідання з кафедрою інфекційних хвороб та кафедрою ендокринології уморфологічному корпусі , аудиторії №5
Он-лайн у Mscrosoft Teams:https://teams.microsoft.com/l/team/19%3AEgMowWmWgUS9NY7gZKlaT3yjyWs7BW5Fg21IepynHmI1%40thread.tacv2/conversations?groupId=8caed205-77d9-4472-a6a5-9007aa5667ff&tenantId=7346d930-ca22-4336-8ec1-7d11541393e4







Штат кафедри
Шевчук Сергій Вікторович
завідувач кафедри, професор, д.мед.н.
Професор С.В. Шевчук проводить консультативну роботу в ревматологічному, терапевтичному відділеннях, а також клінічні розгляди. Під керівництвом С.В. Шевчука захищено 7 кандидатських дисертацій, виконуються ще 3 дисертації.
Google Scholar: https://scholar.google.com/citations?user=C9vL5_UAAAAJ&hl=uk
https://orcid.org/0000-0002-5649-2775
Scopus Author ID: 7004183919
Web of science: https://www.webofscience.com/wos/author/record/Y-8642-2018
Масік Надія Прокопівна
Професор, д.мед.н.
Закінчила лікувальний факультет Вінницького державного медичного інституту імені М. І. Пирогова у 1986 році. Після проходження інтернатури в МКЛ № 2 м.Вінниця з 1988 по 1991 роки працювала лікарем приймального, а потім ординатором терапевтичного відділення центральної районної лікарні м. Хмільник Вінницької області. В 1991 році за конкурсом зарахована на посаду асистента кафедри госпітальної терапії №1 Вінницького ордена “Знак Пошани” медичного інституту імені М.І. Пирогова.
26 жовтня 1998 року захистила кандидатську дисертацію в спеціалізованій вченій раді при Українському НДІ фтизіатрії і пульмонології ім. Г.Ф. Яновського НАМН України за спеціальністю пульмонологія на тему: «Ефективність комбінованої еферентної та медикаментозної терапії у хворих на хронічні обструктивні захворювання легенів» (науковий керівник – завідувач кафедри госпітальної терапії №1 ВНМУ ім. М.І. Пирогова д.мед.н., професор Маленький В.П.) і отримала затвердження ВАК України 13 січня 1999 року. В 2000 р. обрана за конкурсом на посаду доцента кафедри госпітальної терапії №1, а в 2002 році отримала вчене звання доцента.
З 2000 по 2015 рр. виконувала обов’язки завідувача навчальної частини кафедри.
21 лютого 2014 році захистила докторську дисертацію за спеціальністю внутрішні хвороби на тему: «Системні порушення метаболізму кісткової тканини у хворих різних вікових груп з хронічними захворюваннями органів дихання та шляхи їх корекції (клініко-експериментальне дослідження)» (науковий консультант – керівник відділу клінічної фізіології і патології опорно-рухового апарату Інституту геронтології АМН України д.мед.н., професор Поворознюк В.В.) при Державній установі «Кримський державний медичний університет імені С.І. Георгієвського» МОЗ України і отримала затвердження ДАК України 28 червня 2014 р. В 2017 р. обрана за конкурсом на посаду професора кафедри внутрішньої медицини № 2, а в 2021 році отримала вчене звання професора.
У співавторстві з професором Маленьким В.П. видала посібник для самостійної підготовки до практичних занять з госпітальної терапії (2005 р.). Є співавтором навчально-методичного посібника «Невідкладні стани» 2000 р., «Терапія в тестах» 2002 р., колективної монографії «Scientific basis of modern medicine», 2020 р.; монографії «Вторинний остеопороз», 2021 р., автором нарису «Обличчя кафедри госпітальної терапії. Історичний нарис до 80-річчя створення кафедри», 2019 р. Автор 147 наукових робіт у наукових медичних виданнях України та зарубіжжя, у тому числі 7 статей у науко-метричних базах Scopus та Web of Science, 16 – навчально-методичних робіт, власник 7 патентів на винаходи, які стосуються діагностики та лікування захворювань органів дихання і опорно-рухової системи.
За вагомі досягнення у професійній діяльності нагороджена Подякою міністра охорони здоров’я в 2007 р. Нагороджена Почесними грамотами Вінницької обласної Ради та облдержадміністрації в 2010 р., Вінницького національного медичного університету імені М.І. Пирогова в 2011 р. Отримала сертифікат ICH-GCP в 2010 р.
ID ORCID https:// orcid.org/0000-0002-6552-2470
Google Scholar https://scholar.google.com.ua/citations?user=Ox0HhPYAAAAJ&hl=uk
Scopus https://www.scopus.com/authid/detail.uri?authorId=57212674634
Коробко Олена Анатоліївна
Доцент, к.мед.н.
Опубліковано 100 наукових робіт, 1 деклараційний патент на корисну модель та 1 інформаційний лист про нововведення в системі охорони здоров’я.
З грудня 2012 року – на посаді доцента кафедри внутрішньої медицини № 2, з 2015 року - завуч кафедри.
Google Scholar: https://scholar.google.com.ua/citations?user=_JoRqdYAAAAJ&hl=uk&citsig=AMstHGThSNVXDHdq9vYC-rlaSlUhmCHU5A
ORCID: https://orcid.org/0000-0001-5762-1535
Web of Science ResearcherID: GZL-6057-2022
Ільюк Ірина Анатоліївна
Доцент, к.мед.н.
2009 році захистила кандидатську дисертацію за темою: «Ефективність тіотриазоліну в комплексному лікуванні хворих на негоспітальну пневмонію з проявами ендогенної інтоксикації» за спеціальністю 14.01.27 – пульмонологія.
З 2017 року займає посаду доцента кафедри внутрішньої медицини №2.
Опубліковано 60 праць, у тому числі 20 статей у наукових фахових журналах, що входять до переліку ВАК України, 8 статей у наукових фахових журналах, що входять до наукометричних баз Scopus та WoS, 29 – у матеріалах і тезах з’їздів та конференціях різного рівня, отримано 1 деклараційний патент України на винахід та виданий інформаційний лист, 1 посібник та методичні рекомендації.
https://scholar.google.com.ua/citations?view_op=list_works&hl=ru&user=MnHcep8
AAAAJ
https://orcid.org/0000-0003-2525-2653
Scopus Autor ID: 57208736564
Лисенко Дмитро Андрійович
Доцент, к.мед.н.
Навчальні посібники: «Лекції з гематології» - 2005 рік
«Невідкладні стани» - 2002 рік.
Маринич Любов Іванівна
Доцент, к.мед.н.
https://www.webofscience.com/wos/author/record/ABD-7277-2020
https://orcid.org/0000-0003-2191-3477
https://www.scopus.com/authid/detail.uri?authorId=57222739850
Нечипорук Сергій Васильович
Доцент, к.мед.н.
Опубліковано 25 наукових робіт, отримано 2 патенти на винахід.
https://scholar.google.com/citations?user=Je89jVoAAAAJ&hl=ru
в WebO https://www.scopus.com/authid/detail.uri?authorId=57224418436
Некрут Дар'я Олександрівна
Доцент, к.мед.н.
Денищич Людмила Петрівна
Доцент, к.мед.н.
Google scholar:
https://scholar.google.com/citations?user=uaFO3pAAAAAJ
https://orcid.org/0000-0001-9366-8648
Scopus Author ID: 57190862156
Scopus Author ID: 57222739489
Бондарчук Світлана Віталіївна
Асистент
У 1991році закінчила Вінницький медичний інститут імені М.І. Пирогова.
Отримала диплом з відзнакою за спеціальністю лікувальна справа.
Післядипломна освіта: поглиблена інтернатура з терапії (1 рік), клінічна
ординатура з терапії з поглибленим вивченням гематології (2 роки) у
Вінницькому медичному інституті імені М.І. Пирогова, первинна спеціалізація з
гематології у КМАПО імені П.Л. Шупика, регулярні ПАЦ з терапії у ВНМУ
імені М.І. Пирогова, з гематології у ЛНМУ імені Данила Галицького, ТУ з
клінічної фармакології, ТУ з імунології та алергології у НМАПО імені П.Л.
Шупика, військової медицини в Українській військово-медичній академії,
стажування з професійної патології у НМУ імені О.О. Богомольця, стажування
з гематології за кордоном (відділення онкогематології та трансплантації
кісткового мозку, клініка «Medical Park», Стамбул, Туреччина).
З 1992 року здійснює курацію пацієнтів з анеміями, лейкеміями, патологією
гемостазу у клінічному високоспеціалізованому гематологічному відділенні
Вінницької обласної клінічної лікарні імені М.І. Пирогова, консультації
гематолога у інших відділеннях ВОКЛ імені М.І. Пирогова та ЗОЗ у Вінницькій
області.
З 1994 року працює асистентом кафедри внутрішньої медицини №2 ВНМУ
імені М.І. Пирогова. Науковий доробок: 2 винаходи, 7 посібників, 80 публікацій.
Бондарчук С.В. є куратором студентського наукового гуртка кафедри. Регулярно
бере участь в поточних науково-практичних конференціях, майстер-класах,
вебінарах, школах в якості доповідача, автора майстер-класів на освітніх
платформах Асоціації лікарів амбулаторної медицини, АПАМ, МедЕксперт,
Аксемедін.
За сумлінну працю нагороджена подяками ВНМУ імені М.І. Пирогова, орденом
«Берегиня України» ГО «МБФ НУН», та Вітальним листом Голови Верховної
Ради України Руслана Стефанчука
Google Scholar:
https://scholar.google.com.ua/citations?hl=uk&user=gt9c9lgAAAAJ&view_op=list_
works&citft=1&citft=2&citft=3&email_for_op=svitvitbond%40gmail.com&gmla=A
JsN-
F6Ms1s1u_wzb3eYshh61F7tsjeoMC_DfCwLlWuixC3NvU3YkkOXpC2g9dTu6U3i
qYd7CwfxVg4nDcylAeLOg4cLmO2uFZdw0QVndz425Q_k6wpoP_hPMi8hlj8skb4
zH94BNbsy9LdT7j-
OuZN3LHMFym9mXfrwu0qZdbbCWhNKKmbwjAyqkpdGoBou6jD47-
ezgO14oHzU_J4jpPxsKh5SqgJt8dMd-
luPnmoffnUmmPjdHbh90ju3wVhCUuvVoPvUMqTg1UuBiOyQeiVcLCihJ0XS8ow
Y8n5A2jEwVR1OGOVJc7Hs1UbN_KsjiLU7YoCD66b0
Звягіна Оксана Володимирівна
Аcистент, PhD
З 2017 по 2021 рік проходила навчання в аспірантурі за спеціальністю 222 «Медицина». Тема дисертаційного дослідження: «Анемічний синдром у хворих на анкілозивний спондиліт».
З вересня 2018 року працює викладачем-стажистом на кафедрі внутрішніх хвороб №2. З вересня 2021 року – на посаді асистента кафедри внутрішньої хвороби №2.
Автор 19 наукових праць, серед яких 7 статей, опублікованих у журналах, індексованих у базах даних Scopus. Має 4 патенти на винахід.
Сертифікований лікар-терапевт та лікар-кардіолог.
Членство в професійних організаціях:
• Європейське кардіологічне товариство;
• Європейське товариство серцевої недостатності;
• Робоча група з вроджених вад серця у дорослих;
• Асоціація превентивної та антиейджинг медицини.
Google Scholar: https://scholar.google.com/citations?hl=ru&user=V_K0vJIAAAAJ&view_op=list_works
Scopus Author ID: https://www.scopus.com/authid/detail.uri?authorId=57218352075
Orcid:
https://orcid.org/0000-0002-1840-8288
Заічко Катерина Олександрівна
Асистент, PhD
У 2016 р. захистила магістерську роботу, здобувши ступінь магістра медицини.
З 2016 року до 14 вересня 2020 року, аспірантка кафедри внутрішньої медицини №1 в Вінницькому національному медичному університеті ім. М. І. Пирогова МОЗ України, м. Вінниця
У 2021 році захистила дистертацію на ступінь доктора філософії з галузі знань 22 «Охорона здоров’я» під керівництвом професора Станіславчука М.А. на підставі прилюдного захисту дисертації «Циркадні ритми продукції ендотеліальної синтази оксиду азоту та тол-подібних рецепторів 2 у жінок, хворих на ревматоїдний артрит: зв’язок з перебігом захворювання та ефективністю лікування» за спеціальністю 222 «Медицина» Дисертацію виконано у Вінницькому національному медичному університеті ім. М. І. Пирогова МОЗ України, м. Вінниця. Диплом ДР №001190 від 09.02.2021 року.
Авторка 42 наукових публікації, у тому числі 2х патентів. Рецензентка (2020-по теперешній час) Rheumatology international, Springer Nature. Членкиня EULAR та EMEUNET, спікерка освітніх громадських платформ InScience та Progress.
Лікувальну роботу проводить як лікар –ревматолог на базі (2014-2021) Високоспеціалізованого клінічного центру ревматології та біологічної терапії на базі КНП ім. М.І. Пирогова та (2021- по теперешній час) на базі Військово-медичний клінічний центр Центрального регіону (ВМКЦ ЦР).
Павлюк Оксана Миколаївна
Асистент, PhD
У 2016 році закінчила Вінницький національний медичний університет ім. М.І. Пирогова
за спеціальністю «Лікувальна справа».
З 2016 по 2018 роки проходила інтернатуру за спеціальністю «Внутрішні хвороби», по
закінченню якої було присвоєно звання лікаря-спеціаліста.
З 2018 по 2022 рік навчалася в аспірантурі за спеціальністю 222 Медицина.
У 2023 році захистила дисертацію на тему «Метаболічні фактори ризику порушень
структурно-функціонального стану кісткової тканини у чоловіків, хворих на анкілозивний
спондиліт» за спеціальністю 222 «Медицина»
З 2020 року – секретар Ради молодих вчених.
З 2020 року – експерт із акредитації освітніх програм Національного агентства із
забезпечення якості вищої освіти.
З вересня 2020 року працювала викладачем - стажистом на кафедрі внутрішньої медицини
№2.
З вересня 2022 р. працює асистентом кафедри внутрішньої медицини №2.
Є автором 25 наукових праць, у тому числі 8 статей (включаючи наукові журнали,
індексовані наукометричною базою даних Scopus).
https://scholar.google.com.ua/citations?user=dMZ1MAcAAAAJ&hl=uk
https://orcid.org/0000-0002-5582-3800
Scopus Author ID: 57288176200
Степанюк Тетяна Володимирівна
Асистент, Аспірант
1998р. - 1999р. – інтернатура по терапіі на базі кафедри госпітальної терапії Вінницького державного медичного університету ім. М.І. Пирогова.
З 2009р. - по2011р. навчалась в клінічній ординатурі за спеціальністю «терапія» при кафедрі внутрішньої медицини №2 ВНМУ ім. М.І. Пирогова. Має вищу атестаційну категорію лікаря терапевта.
В 2021 році закінчила курси спеціалізації з пульмонології та отримала сертифікат лікаря-спеціаліста за спеціальністю «Пульмонологія».
В 2023 році закінчила курси та отримала сертифікат лікаря-спеціаліста за спеціальністю «Фізична та реабілітаційна медицина».
В 2018 році була нагороджена Почесною грамотою Вінницького національного медичного університету ім. М.І. Пирогова.
Член Європейського респіраторного товариства ( ERS) з 2024 року.
Опубліковано 20 наукових робіт. Виконує обов′язки профорга кафедри.
Мальована Тетяна Сергіївна
Асистент, аспірант
Google Scholar: https://scholar.google.com.ua/citations?user=m632tV4AAAAJ&hl=uk
ORCID: https://orcid.org/0009-0003-8210-4072
Побережець Анна Олександрівна
Асистент, Аспірант
2016-2018 рр. – інтернатура за спеціальністю «Загальна практика-сімейна медицина».
2018-2023 рр. – лікар загальної практики-сімейний лікар в КНП «Центр первинної медико-санітарної допомоги №2 м. Вінниці».
2023 р. – пройшла спеціалізацію за фахом «Терапія».
З 2023 року навчається в аспірантурі для здобуття ступеня доктора філософії за спеціальністю «222 Медицина».
З 2023 р. – викладач-стажист кафедри внутрішньої медицини №2.
З 2024 р. – асистент кафедри внутрішньої медицини №2.
Член Європейської спільноти молодих ревматологів (EMEUNET) з 2024 р., член Європейського респіраторного товариства (ERS) з 2019 р., член Європейської академії алергії та клінічної імунології (EAACI) з 2023 р.
Є автором 12 тез, опублікованих в збірниках матеріалів конференцій студентів та молодих вчених.
Солєйко Олена Віталіївна
Роки роботи на кафедрі: 1996 - 2020
Професор, д.мед.н.
Солєйко Олена Віталіївна – доктор медичних наук, професор, лікар-терапевт вищої категорії, дійсний член міжнародної організації «Асоціація превентивної та антиейджинг медицини» за підтримки WOSAAM, A4M, IHS з 2009 р., магістр з публічного управління та адміністрування.
Після закінчення з відзнакою Вінницького медичного інституту ім. М.І. Пирогова, клінічної ординатури та аспірантури з фаху «Кардіологія» і захисту дисертації на здобуття наукового ступеня кандидата медичних наук «Особливості діагностики та прогнозування серцевої недостатності при дилатаційній кардіоміопатії: клініко-математичне моделювання» у 1996 році в Спеціалізованій вченій раді Українського науково-дослідного інституту кардіології ім. акад. М.Д. Стражеска МОЗ України працювала на кафедрі внутрішньої медицини № 2 з 1996 по 2020 рік.
У 2008 році захистила дисертацію на здобуття наукового ступеня доктора медичних наук «Хронічна постінфарктна аневризма серця: аспекти патогенезу, діагностики та лікування» у Спеціалізованій вченій раді Д 20.601.01 «Кардіологія» при ДВНЗ «Івано-Франківський державний медичний університет» МОЗ України. У 2009 році отримала вчене звання доцента, у 2014 – вчене звання професора.
Автор понад 350 наукових праць у наукових медичних виданнях України та зарубіжжя, у тому числі 8 статей у наукометричних базах Scopus та Web of Science, науково-популярних статей і нарисів, зокрема статті «Аневризма серця» у Великій українській енциклопедії (2020 р.), 10 патентів на винахід, 4 навчальних посібників, 2 монографій, зокрема, «Синдром недиференційованої дисплазіїї сполучної тканини: від концепції патогенезу до стратегії лікування»: Навчальний посібник для студентів вищих медичних навчальних закладів ІІІ-IV рівнів акредитації. Вінниця: Нова Книга, 2014. 168 с. (Солєйко О.В., Рикало Н.А., Осипенко І.П., Солейко Л.П.) та монографії «Хронічна постінфарктна аневризма серця». Київ: Видавничий дім Медкнига, 2018. 184 с. (Солєйко О.В., Солейко Л.П.).
Під керівництвом професора Солєйко О.В. 2 здобувача одержали науковий ступінь кандидата медичних наук із спеціальності «Кардіологія»: Осипенко Ірина Павлівна – «Маркери дисплазії сполучної тканини у хворих з ідіопатичним пролабуванням мітрального клапану та принципи колагенонормалізуючої терапії» у 2013 р. та Черних Марія Олександрівна – «Ішемічна хвороба серця на тлі недиференційованої дисплазії сполучної тканини: особливості перебігу, аспекти діагностики та пронозу» у 2016 р.
Автор та керівник студентських науково-мистецьких проєктів, фестивалю мультимедійних наукових проєктів з професійних хвороб «Проффі», який у 2019 році відзначив своє десятиріччя, член журі Всеукраїнської олімпіади з внутрішньої медицини, м. Київ (2019 р.), член робочої групи МОЗ України з деяких питань проходження інтернатури за спеціальністю «Внутрішні хвороби» 2019-2020 рр.
Історик медицини, краєзнавець. Співавтор чотирьох науково-історичних монографій: «Лікарня на Замості» 1998 р., «Професор Федір Мерінг: повернення в історію вітчизняної науки» 2005 р., «Медицина в літературі та живописі» 2007 р., «Зірка Григорія Артинова, першого Вінницького Міського Архітектора» 2012 р. Автор ідей, ілюстратор та організатор виставок до 150-річчя від дня народження архітектора Г.Г. Артинова «Вінниця очима Артинова, Артинов очима вінничан» (2010 р.), до 190-річчя від дня народження професора медицини Ф.Ф. Мерінга «Митець у лікуванні, лікар у мистецтві» (2012 р.).
Володар гранту Європейського Будинку Серця, учасник Міжнародних наукових проєктів у 2017 та 2018 роках, лауреат Подільської літературно-мистецької премії «Кришталева вишня» 2005 р. Нагороджена Почесними грамотами Вінницької облдержадміністрації та обласної ради: у 2004 р. – за плідну раціоналізаторську та винахідницьку діяльність, у 2010, 2011, 2012 рр. – за сумлінну працю, плідну краєзнавчу та літературну діяльність із вивчення та популяризації взаємозв’язків медицини та мистецтва Вінниччини, у 2016 р. – за значний особистий внесок у розвиток медичної освіти і науки та високий професіоналізм.
Атаманчук Микола Степанович
Роки роботи на кафедрі: 1984 - 2020
Доцент, к.мед.н.
В 1952 році з відзнакою закінчив Сорокську фельдшерсько-акушерську школу за спеціальністю фельдшер.
В 1958 році з відзнакою закінчив Кишинівський Державний медичний інститут за спеціальністю лікар.
З 1958 по 1961 рр працював лікарем у Великокісницькій лікарській дільниці.
В 1961-1963 рр. - клінічна ординатура на базі кафедри факультетської терапії Станіславського (Івано-Франківського) медичного інституту.
З 1963 по 1964 рр працював завідувачем терапевтичного відділення в Калуській районній лікарні.
З 1964 по 1966 рр навчався в аспірантурі на базі кафедрі госпітальної терапії Київського медичного інституту.
З 1966 по 1980 рр працював асистентом, доцентом на кафедрі внутрішніх хвороб стоматологічного факультету Донецького медичного інституту. У 1968 році захистив дисертацію та отримав звання кандидата медичних наук.
З 1980 по 1984 рр працював у Вінницькій філії ДІВЕТІНу (сьогодні це Науково-дослідницький інститут реабілітації осіб з інвалідністю) на посадах старшого наукового співробітника, керівника клінічних досліджень, заступника директора інституту.
З 1984 р. прийнятий на посаду асистента кафедри внутрішніх хвороб №2 Вінницького медичного інституту. У 1989 році переведений на посаду доцента кафедри госпітальної терапії №2 Вінницького Державного медичного університету. Пропрацював на кафедрі до 2020 року. Помер 29.11.2022 року.
Откаленко Юрій Костянтинович
Роки роботи на кафедрі: 1992 - 2021
доцент, к.мед.н.
Після закінчення інтернатури з 1973 по 1974 рр працював лікарем блоку інтенсивної терапії та реанімації відділення кардіології на базі МКЛ № 4 м. Вінниці (нині МКЛ № 1).
З 1974 по 1980 рр. – науковий співробітник терапевтичного відділення Вінницького науково-дослідного інституту експертизи та реабілітації інвалідів.
З 1 квітня 1980 року за конкурсом був прийнятий на посаду асистента кафедри госпітальної терапії № 1.
В 1982 році на спеціалізованій Раді Київського НДІ ендокринології і обміну речовин захистив кандидатську дисертацію на тему: «Функциональное состояние сердечно-сосудистой системы и липидный обмен у больных гипотиреозом» (науковий керівник проф. Б.О.Зелінський).
У 1992 році отримав звання доцента кафедри госпітальної терапії № 1. В цьому ж році переведений на кафедру госпітальной терапії № 2 (зараз кафедра внутрішньої медицини № 2) Вінницького медичного інституту ім. М.І. Пирогова. Проводив практичні заняття та читав лекції студентам з внутрішньої медицини, професійних хвороб, вертебрології та гомеопатії.
З 1990 року – лікар вищої категорії за фахом «терапія». Систематично здійснював лікувально-профілактичну роботу. Крім курації хворих, проводив консультативну роботу в різних відділеннях МКЛ 1, МКЛ 2, МКЛ 3 та міському кардіологічному диспансері.
Брав участь в численних науково-практичних конференціях, конгресах, семінарах та симпозіумах.
Автор більше 100 друкованих робіт, 18 раціоналізаторських пропозицій, одного винаходу.
Сегеда Юлія Сергіївна
Роки роботи на кафедрі: 2014 - 2024
доцент, к.мед.н.
Кувікова Інна Петрівна
Роки роботи на кафедрі: 2018 - 2024
Асистент, К.мед.н.
З 2013 р. науковий співробітник відділу реабілітації пацієнтів з ревматологічними захворюваннями Науково дослідного інституту реабілітації інвалідів МОЗ України.
В 2018 році захистила кандидатську дисертацію за спеціальністю 14.01.12 – ревматологія, на тему: «Гіпергомоцистеїнемія та асоційовані з нею метаболічні порушення як фактори ризику ураження судин у хворих на антифосфоліпідний синдром».
Автор 17 наукових праць, в тому числі 6 статей в фахових виданнях, рекомендованих ВАК України, 11 – в матеріалах конгресів та конференцій, отримано 5 деклараційних патентів України, 6 нововведень.
Має першу кваліфікаційну категорію зі спеціальності «терапія» та першу кваліфікаційну категорію зі спеціальності «ревматологія».
Лікувальну роботу виконує в ревматологічному відділенні Науково дослідного інституту реабілітації інвалідів (ннлк) ВНМУ ім. М.І. Пирогова.
Новини
РЕЗУЛЬТАТИ
першого (вузівського) етапу Всеукраїнської студентської олімпіади з внутрішньої медицини, що відбувся на кафедрі внутрішньої медицини № 2 ВНМУ ім. М. І. Пирогова
26 березня 2026 року
5 курс
|
№ пп |
ПІП |
група |
бали |
% |
|
Свиридюк Альона Романівна |
12б |
49 |
90 |
|
|
Дубей Марія Василівна |
13а |
46 |
85 |
|
|
Бородатий Ярослав Олександрович |
11а |
37 |
68 |
|
|
Люткевич Анна Сергіївна |
12б |
36 |
65 |
|
|
Соломка Карина Анатоліївна |
8б |
34 |
61 |
|
|
Клименко Софія Юріївна |
13а |
33 |
60 |
|
|
Ревуцький Юрій Олександрович |
7а |
33 |
60 |
|
|
Качур Ірина Вікторівна |
11а |
30 |
52 |
|
|
Муся Роман Сергійович |
6б |
30 |
52 |
|
|
Ткачук Віталія Віталіївна |
8б |
29 |
51 |
|
|
Черняк Маргарита Олександрівна |
11а |
29 |
51 |
|
|
Гура Інна Андріївна |
11б |
29 |
51 |
|
|
Лабиш Анна Дмитрівна |
8б |
29 |
51 |
|
|
Кес Олена Юріївна |
8б |
28 |
50 |
|
|
Мальована Анастасія Олександрівна |
14а |
28 |
50 |
|
|
Любечко Олександра Валеріївна |
14а |
28 |
50 |
|
|
Ковтанюк Богдан Олегович |
12б |
28 |
50 |
|
|
Швабська Аліна Назаріївна |
8б |
28 |
50 |
|
|
Остапчук Анастасія Віталіївна |
11а |
28 |
50 |
4 курс
|
№ пп |
ПІП |
група |
бали |
% |
|
Бахур Максим Сергійович |
6а |
48 |
87 |
|
|
Колесова Марія Олександрівна |
6а |
40 |
72 |
|
|
Пилипенко Надія Віталіївна |
7а |
38 |
70 |
|
|
Гінгін Анна Ігорівна |
7а |
36 |
65 |
|
|
Ященко Артур Русланович |
9а |
35 |
64 |
|
|
Лєснік Валерія Валеріївна |
15а |
35 |
64 |
|
|
Комар Ольга Олександрівна |
15а |
33 |
60 |
|
|
Шилова Софія Віталіївна |
6б |
31 |
56 |
|
|
Шоханов Нікіта Андрійович |
7а |
31 |
56 |
|
|
Першин Микита Юрійович |
8а |
30 |
55 |
|
|
Маковчук Марина Денисівна |
8б |
29 |
53 |
|
|
Усата Ольга Андріївна |
6а |
28 |
50 |
|
|
Науменко Нікіта Юрійович |
15а |
28 |
50 |
|
|
Москалець Тетяна Миколаївна |
8б |
28 |
50 |
|
|
Полеся Катерина Русланівна |
8б |
28 |
50 |
|
|
Тварковська Анна Андріївна |
12б |
28 |
50 |
|
|
Литвин Елана В’ячеславівна |
8а |
28 |
50 |
ПРИЗЕРИ ОЛІМПІАДИ
5 курс
Свиридюк Альона Романівна - І місце
Дубей Марія Василівна - ІІ місце
Бородатий Ярослав Олександрович - ІІІ місце
4 курс
Бахур Максим Сергійович - І місце
Колесова Марія Олександрівна - ІІ місце
Пилипенко Надія Віталіївна - ІІІ місце
Завідувач кафедри
внутрішньої медицини № 2
д. мед. н., професор ЗВО Сергій ШЕВЧУК
ОГОЛОШЕННЯ
26 березня 2026 року о 17:00 відбудеться олімпіада з внутрішньої медицини
серед студентів 4-го та 5-го курсів
на кафедрі внутрішньої медицини № 2
за адресою: вул. Хмельницьке шосе, 104
(Університетська клініка ВНМУ ім. М.І. Пирогова)

Захист практики відбуватиметься з 9.00 до 13.00
16 червня 2025 року о 09.00 на кафедрівнутрішньої медицини №2 (за адресою: вул.Хмельницьке шосе, 104) відбудеться перездачаіспиту для студентів 4 курсу.
РОЗКЛАД ОСКІ
із внутрішньої медицини
для студентів 4 курсу
VIII семестр 2024-2025 навчальний рік
|
Дата |
Група |
Час |
|
06.06.2025 |
6-а |
8:30 |
|
6-б |
9:00 |
|
|
7-а |
9:30 |
|
|
7-б |
10:00 |
|
|
8-а |
10:30 |
|
|
8-б |
11:00 |
|
|
09.06.2025 |
11-а |
8:30 |
|
11-б |
9:00 |
|
|
12-а |
9:30 |
|
|
12-б |
10:00 |
|
|
13-а |
10:30 |
|
|
13-б |
11:00 |
|
|
13.06.2025 |
14-а |
8:30 |
.
ОСКІ проводяться на базі кафедри внутрішньої медицини №2 за адресою: вул. Хмельницьке шосе, 104.
Із собою необхідно мати документ, який підтверджує особу (студентський квиток, паспорт, водійське посвідчення).
ОГОЛОШЕННЯ
5 червня о 10.00 на кафедрі внутрішньої медицини № 2 (вул. Хмельницьке шосе, 104) відбудеться консультація щодо проведення ОСКІ для студентів 4-го курсу.

ОГОЛОШЕННЯ
29 квітня 2025 року о 17:00 відбудеться олімпіада з внутрішньої медицини
серед студентів 4-го та 5-го курсів
на кафедрі внутрішньої медицини № 2
за адресою: вул. Хмельницьке шосе, 104
(Університетська лікарня ВНМУ ім. М.І. Пирогова)


https://teams.microsoft.com/l/channel/19%3A2nauRqV2jet5i08i--fnRMvUIJeGOpcZUJ00JKz5VAw1%40thread.tacv2/?groupId=4418694a-cdf1-4ecc-95f0-ae72a29a1ffb&tenantId=7346d930-ca22-4336-8ec1-7d11541393e4


https://teams.microsoft.com/l/team/19%3AEgMowWmWgUS9NY7gZKlaT3yjyWs7BW5Fg21IepynHmI1%40thread.tacv2/conversations?groupId=8caed205-77d9-4472-a6a5-9007aa5667ff&tenantId=7346d930-ca22-4336-8ec1-7d11541393e4

https://teams.microsoft.com/l/team/19%3AEgMowWmWgUS9NY7gZKlaT3yjyWs7BW5Fg21IepynHmI1%40thread.tacv2/conversations?groupId=8caed205-77d9-4472-a6a5-9007aa5667ff&tenantId=7346d930-ca22-4336-8ec1-7d11541393e4
28 листопада 2024 року о 12.30 відбудеться відкрита лекція к. мед. н., доцента кафедри внутрішньої медицини №2 Некрут Д.О. Лекція розміщена на сайті кафедри внутрішньої медицини #2 за посиланням https://drive.google.com/file/d/1qYOafoLTagudHSv3y1qPqTR4khr0VS6c/view?usp=drivesdk
Тема лекції – « Хронічний панкреатит»







21 вересня 2020 року о 9.00 відбудеться перездача іспиту з внутрішньої медицини для студентів 4 та 5 курсів
Студент, який планує взяти участь у перездачі, повинен повідомити про це свого викладача до 18.09.2020 р.
21 вересня 2020 року о 9.00 відбудеться перездача іспиту з внутрішньої медицини для студентів 4 та 5 курсів
Студент, який планує взяти участь у перездачі, повинен повідомити про це свого викладача до 18.09.2020 р.
Наукова діяльність
Кафедра госпітальної терапії (тепер внутрішньої медицини № 2) була створена в серпні 1936 р. Усі ці славетні роки поряд із першочерговим завданням – підготовкою висококваліфікованого фахівця – крокував і науковий напрям роботи.
В довоєнний період колектив кафедри працював над проблемою діагностики та лікування захворювань серцево-судинної системи та шлунково-кишкового тракту (проф. Ю.Я. Фішензон, асистенти М.Ф. Шинкарьова, С.Д. Заславська). У повоєнні роки кафедра поновлює свою наукову діяльність під керівництвом професорів – завідувачів кафедри В.О. Азлецького, Я.М. Бритвана, Б.Д. Давидова, Б.І. Лідського. У цей період наукова тематика кафедри була пов'язана з вивченням патології серцево-судинної системи та захворювань системи крові (асистенти І.А. Рибачук, В.М. Пілат, А.С. Ройзман, І.Я. Розенберг, Г.Г. Сергеєва, С.С. Мільштейн). Вийшла друком монографія Лідського Б.Й. "Практическое пособие по лекарственной терапии внутренних болезней".
За період завідування кафедрою проф. Піайдом Ф.Ф. (1952-1956 рр.) пріоритетними науковими дослідженнями були питання онкології. Під керівництвом Піайда Ф.Ф. були виконані кандидатські дисертації:
Чуберкіс Т.П. «Функциональное состояние сердечно-сосудистой системы при раке внутренних органов»
Кучеренко О.М. «Антитоксическая функция печени при раке внутренних органов».
За час завідування кафедрою проф. Колотовою Н.М. (1956-1961 рр.) наукові інтереси співробітників кафедри були пов'язані з вивченням захворювань системи крові. В результаті наукових пошуків вийшла друком монографія проф. Н.М. Колотової "Полицитемия", захищена кандидатська дисертація Войтюк В.М., надруковано 48 наукових статей. Співробітники кафедри вивчали і оволоділи методиками лікування та діагностики з використанням радіоактивних ізотопів (Кучеренко О.М., Чуберкіс Т.П.). Захищена кандидатська дисертація Головцева Ю.М. на тему «Осмотична резистентність еритроцитів при захворюваннях серцево-судинної системи» (1955 р.).
За час завідування кафедрою доц. Головцевим Ю.М. (1961-1967 рр.) на кафедрі впроваджено нові методи обстеження хворих з атеросклерозом й іншими захворюваннями серцево-судинної системи, такі як механокардіографія, полікардіографія, оксигемографія, пламенна фотометрія та інші. Наукові інтереси кафедри передовсім стосувалися вивчення екстракардіальних форм ревматизму, ревматичного пошкодження магістральних судин кінцівок, функціонального стану серцево-судинної системи при нейроциркуляторній дистонії, клінічного перебігу та лікування хронічного холециститу, ангіохоліту, хронічного гастриту, виразкової хвороби.
Захищено кандидатські дисертації:
Сокол А.Е. «Стан гемодинаміки у хворих з Аддісоновою хворобою»,
Завальнюк Н.Ф. «Біохімічні зрушення у хворих на атеросклероз під впливом йодистої терапії».
Довгаленко В.П. "Зміна харчового слиновиділення при деяких шлунково-кишкових захворюваннях" (1965 р.).
У час завідування кафедрою проф. Кучуком О.П. (1967-1991 рр.) на кафедрі виконується потужна педагогічна, наукова і лікувальна робота. Саме цей період можна назвати розквітом медичної науки і практики. Наукові інтереси кафедри в цей час були пов'язані з вивченням глютаміноаспарагінової трансамінази у хворих з гіпо- і апластичними анеміями, гострим і хронічним лейкозами, факторів згортання, природних антикоагулянтів і фібринолізу при консервації крові, функції кори наднирників і уропепсиногену у хворих на інфаркт міокарду. Клініка була забезпечена необхідними матеріалами, була створена потужна лабораторія. Тому не дивно, що за останні 5 років опубліковано 37 наукових робіт.
Захищені докторські дисертації:
Кучеренко О.М. «О происхождении, клинических проявлениях и классификации некоторых гипертонических состояниях и начальной стадии гипертонической болезни у лиц юношеского и молодого возраста» (1971 р.);
Шкляр М.Б. «Состояние гемодинамики при артериальных гипотониях различного генеза: вопросы патогенеза, клиники и лечения» (1971 р.),
Головцев Ю.М. «Матеріали до вивчення функціональних порушень печінки при атеросклерозі і патогенетичне обґрунтування деяких видів його лікування» (1971 р.).
Захищені кандидатські дисертації:
Жук Н.С. «Показатели свертывающей и антисвертывающей систем крови у больных деструктивными формами туберкулеза при операциях на легких»;
Новицький Г.А. «Лечение больных инфекционным неспецифическим полиартритом углекисло-радоновыми водами с пониженным содержанием дейтерия на курорте «Хмельник»;
Проценко Л.Ф. «О патогенезе анемии при диффузном нефрите у детей»;
Виктора В.А. «Особенности течения беременности, родов и послеродового периода у женщин, страдающих ревматическими пороками сердца».
Чернобровий В. М. «Радиотелеметрические показатели функционального состояния желудка у больных язвенной болезнью и хроническим гастритом» (1970 р.);
Яковлева О. О. «Коморбідні зв’язки бронхо-легеневих захворювань з порушеннями шлунку» (1974 р.);
Черешнюк Л. В. «Функціональний стан міокарда у хворих з запальними захворюваннями піднебінних мигдаликів» (1980 р.);
Шанчук О. Г. «Заболевания органов дыхания у рабочих производства синтетических моющих средств» (1986 р.).
У 1971 р. під загальною редакцією М.Б. Шкляра перевиданий підручник "Діагностика внутрішніх хвороб" Бориса Соломоновича Шкляра, який був доповнений новими розділами.
Надруковані методичні матеріали: "Методические указания для студентов VI курса к практическим занятиям по неотложной помощи и интенсивной терапии при некоторых ургентных состояниях в клинике внутренних болезней", "Пути совершенствования клинического мышления в интернатуре по терапии", "Работа врачей-интернов терапевтического профиля в поликлинике", "Методика расшифровки ЭКГ", "Дифференциальная диагностика бронхообструктивного синдрома", „Техника и методика усовершенствования внутриполостной рН-метрии верхнего отдела желудочно-кишечного тракта", "Клиническое применение индикатора кислотности желудка" (В.М. Чернобровий, Н.А. Півторак), "Способы диагностики метаболической функции легких и возможности ее коррекции" (О.О. Яковлева),
Захищено три докторські дисертації:
Маленький В.П.: "Епідеміологія, клініка, діагностика, лікування і профілактика хронічного бронхіту у механізаторів сільського господарства" (1989 р.);
Чернобровий В.М.: "Шляхи поліпшення діагностики і лікування виразкової хвороби і хронічного гастриту (досягнення та перспективи внутрішньо-шлункової рН-метрії" (1989 р.);
Яковлєва О.О.: "Диференційна діагностика ліпідного гемостазу у хворих неспецифічними захворюваннями легенів та обгрунтування метаболічної корекції вітамінами А та В" (1991 р.).
За період з 1981 по 1990 рр. співробітниками кафедри опубліковано 48 наукових робіт. Пріоритетними стали дослідження порушення функцій сурфактантної системи легень, складу конденсату видихуваного повітря (що стало мотивом для розуміння видільної функції легень), вторинних дисліпідемій, поглибленого вивчення наслідків оксидативного стресу, його впливи на фосфоліпідний склад мембран, забезпеченість токоферолом у хворих з гострими та хронічними обструктивними захворюваннями легень.
Кафедра у період незалежної України
З 1992 по 2008 рр. кафедру очолював проф. В.П. Маленький. Основними напрямками наукових досліджень співробітників кафедри, як і раніше, є проблеми пульмонології, гастроентерології і професійних захворювань. Зокрема, виконуються дві науково-дослідні роботи кафедри, проводяться пошуки зі застосування ентеросорбента полісорбу при лікуванні хворих гострими та хронічними запальними процесами бронхо-легеневої системи і органів травлення. За результатами наукових досліджень лише за три роки опубліковано 56 праць, проведена І-ша Подільська науково-практична конференція гастроентерологів. На кафедрі здійснюється клінічна оцінка нової медичної техніки для спелео- та фітотерапії, впроваджено фібробронхоендоскопічне обстеження хворих.
Захищено кандидатські дисертації:
Півторак Н. А. "Критерії доклінічної діагностики і особливості амбулаторного лікування загострень виразкової хвороби дванадцятипалої кишки" (1993 р.);
Масік Н.П. «Ефективність комбінованої еферентної та медикаментозної терапії у хворих на хронічні обструктивні захворювання легенів» (1998 р.);
Шанчук О.М. «Клінічний перебіг хронічного гнійного бронхіту при комплексному лікуванні з використанням ендобронхіальних санацій розчином декаметоксину» (1998 р.);
Корнєєв Б.І. «Особливості діагностики та фармакотерапії хронічного безкам’яного холециститу у зв’язку з порушеннями функціонально-морфологічного стану слизової оболонки шлунка» (1998 р.).
У новому тисячолітті (ХХІ ст.) творча енергія співробітників кафедри спрямована на активну співпрацю з деякими науково-дослідними інститутами АМН України, зокрема з інститутом гематології та трансфузіології, інститутом геронтології. Основними напрямками наукових досліджень співробітників кафедри, як і раніше, є проблеми пульмонології, а також гематології, вертебрології.
11 квітня 2000 року проведено всеукраїнську науково-практичну конференцію «Невідкладні стани в медицині», яка присвячувалась ювілею МКЛ №2 м. Вінниці.
Захищено кандидатські дисертації:
Нечипорук С. В. «Корекція стану кардіореспіраторної системи методом гіпокситерапії у хворих на хронічний обструктивний бронхіт» (2001 р.);
Лисенко Д.А. «Клініко-імунологічний моніторинг хворих на хронічну мієлоїдну лейкемію на фоні хіміотерапії та імунокорекції» (2002 р.);
Черноброва О.І. «Особливості перебігу та лікування анемії, що зумовлена комбінацією дефіциту заліза і вітаміну В12» (2007 р.);
Коробко О. А. «Оптимізація лікування хворих на бронхіальну астму середньої тяжкості із застосуванням акустичного вібромасажу легень» (2009 р.);
Ільюк І. А. «Ефективність тіотриазоліну в комплексному лікуванні хворих на негоспітальну пневмонію з проявами ендогенної інтоксикації» (2009 р.).
Захищено докторські дисертації:
Колісник П.Ф. «Патологія хребта як ланка патогенезу захворювань внутрішніх органів та фактор їх резистентності до лікування» (2002 р.);
Солєйко О.В. «Хронічна постінфарктна аневризма серця: аспекти патогенезу, діагностики та лікування» (2008 р.).
Видано навчальні посібники: 1) Професійні хвороби. За редакцією В.П. Маленького (2005 р.); 2) Невідкладні стани в медицині (2000 р.); 3) В.П. Маленький. Терапія в тестах. (2002 р.); 4) Лекції з гематології / П.М. Перехрестенко, Л.М. Ісакова, Н.М. Третяк, Д.А. Лисенко, С.В. Бондарчук (2005 р.); 5) Госпітальна терапія (посібник для самостійної підготовки до практичних занять) / В.П. Маленький, Н.П. Масік (2005 р.).
Під керівництвом проф. Колісника П.Ф. (2008-2013 рр.) співробітниками кафедри виконані науково-дослідні роботи «Особливості лікувально-реабілітаційних заходів при захворюваннях внутрішніх органів і систем у пацієнтів з супутньою патологією хребта», «Розробка програм багаторівневої медичної реабілітації при захворюваннях внутрішніх органів та систем».
В рамках НДР надруковано 157 наукових робіт, видано 2 методичних рекомендації, 3 підручники, 2 монографії, 17 раціональних пропозицій, отримано 22 патенти, створено пристрої: 1) для проведення лікувальної гімнастики в тракційно-тренуючому режимі, 2) електронний вимірювач станової сили людини (пристрій для моделювання нейрона), 3) пристрій для лікування хворих з вертебральною патологією грудного і поперекового відділу хребта. Видані підручники: 1) Павлов С.В., Кожем’яко В.П., Колісник П.Ф., Василенко В.Б., Козловські Т.І., Думенко В.П. Фізичні основи біомедичної оптики (2010); 2) Павлов С.В., Тимчик Г.С., Кожемяко В.П., Готра З.Ю., Колісник П.Ф., Козловська Т.І. Оптико-електронні медичні системи (2011); 3) Лисенко Д.А. Онкогематологія (розділ у посібнику) / Клінічна онкологія: посіб. для студ. ВМНЗ IV рівня акредитації та лікарів-інтернів: присвяч. 200-річчю з дня народж. видатного вчен. М. І. Пирогова / Б.А. Болюх [та ін.]; ред. Б.А. Болюх. (2012); 4) Фотоплетизмографічні технології контролю серцево-судинної системи / Колісник П.Ф. (2012).
Було захищено кандидатські дисертації:
Хомовський В.В. «Вертеброгенні предиктори артеріальної гіпертензії, диференційно-діагностичні критерії та особливості лікування» (2007 р.);
Гуменюк І. П. „Особливості клінічного перебігу, діагностики та лікування хронічного обструктивного захворювання легень при супутній патології хребта” (2010 р.);
Кравець Р. А. «Особливості перебігу, діагностики та лікування кардіалгій та аритмій серця при дорсопатіях та остеопорозі хребта» (2010 р.);
Березюк О. М. «Значення еритропоетину в розвитку анемічного синдрому при гострій мієлоїдній лейкемії» (2011 р.);
Осипенко І. П. «Маркери дисплазії сполучної тканини у хворих з ідіопатичним пролабуванням мітрального клапану та принципи колагенонормалізуючої терапії» (2013 р.).
З вересня 2013 року посаду завідувача кафедри займає д. мед. н., професор Шевчук С. В. Провідний напрям наукової діяльності кафедри – дослідження та вирішення проблем сучасної ревматології. За останнє десятиріччя колективом кафедри було надруковано 230 статей у фахових журналах, 217 тез у матеріалах як науково-практичних конференцій, так і конгресів світового рівня; видано 1 підручник, 2 монографії, 5 навчальних посібників, зокрема, «Сучасні підходи до реабілітації інвалідів працездатного віку внаслідок хвороб органів дихання» (Шевчук В.І., Забур’янова В.Ю., Вернигородська М.В., Шевчук С.В., Ільюк І.А., Коробко О.А., 2014 р.), «Синдром недиференційованої дисплазії сполучної тканини: від концепції патогенезу до стратегії лікування» (Солєйко О.В., Рикало Н.А., Осипенко І.П., Солейко Л.П., 2014 р.), 3 методичних рекомендації (2012-2013 рр.), 19 інформаційних листів, 37 патентів на винаходи та корисні моделі.
З 2013 р. кафедра є базою Фармакологічного комітету України з випробувань нових лікарських препаратів, бере участь в проведенні міжнародних рандомізованих контрольованих клінічних досліджень, співпрацює з іншими науковими закладами – Інститутом кардіології ім. М.Д. Стражеска, НДІ геронтології імені Д.Ф. Чеботарьова НАМН України, Українським НДІ реабілітації інвалідів та іншими кафедрами університету. На кафедрі виконувались науково-дослідні роботи «Вивчення закономірностей формування серцево-судинних уражень у хворих на антифосфоліпідний синдром та розробити диференційовані підходи до їх фармакологічної корекції», «Вивчити роль клінічних, молекулярно-генетичних, метаболічних, імунозапальних та гемокоагуляційних чинників у формуванні серцево-судинних уражень при ревматоїдному артриті та розробити рекомендації з їх профілактики та лікування», «Вивчити клінічні, метаболічні, генетичні та імунозапальні чинники розвитку остеопорозу та саркопенії у хворих на системний червоний вовчак та розробити підходи до їх фармакологічної корекції».
Захищена докторська дисертація Масік Н. П. «Системні порушення метаболізму кісткової тканини у хворих різних вікових груп з хронічними захворюваннями органів дихання та шляхи їх корекції (клініко-експериментальне дослідження)» (2014 р.).
Захищено кандидатські дисертації:
Куриленко І.В. «Анемічний синдром у хворих на системний червоний вовчак» (2013 р.);
Сегеда Ю.С. «Фактори ризику атеросклеротичного ураження судин у хворих на антифосфоліпідний синдром» (2015 р.);
Черних М.О. «Ішемічна хвороба серця на тлі недиференційованої дисплазії сполучної тканини: особливості перебігу, аспекти діагностики та прогнозу» (2016 р.).
З кінця 2019 р. весь світ і Україна боролися з пандемією COVID-19, а з лютого 2022 р. – з повномасштабним вторгненням росії. Не зважаючи на неймовірні випробування, які випали на долю українців, співробітники кафедри продовжують наукові дослідження, виконуючи НДР «Генетичні та середовищні чинники ризику розвитку остеопорозу та його ускладнень у хворих на ревматичні захворювання». Опубліковано 67 статей у наукових медичних виданнях України та зарубіжжя, 31 статей у науко-метричних базах Scopus та Web of Science, 40 тез, 9 патентів на винаходи і корисні моделі, 5 нововведень, 2 монографії [1) Вторинний остеопороз За ред. Поворознюка В.В., Григор’євої Н.В., Дедух Н.В. Кропивницький. Поліум, 2021.-528 с., Тираж 100 пр. (Масік Н.П. 14 розділ, С.439-469.), 2) Liudmyla Denyshchych, Sergii Shevchuk Advances in Health and Disease. Volume 75 Published by Nova Science Publishers, Inc., New York, USA, 2023, pp. 233. ISBN: 979-8-89113-189-7.] і 2 посібники [1) Актуальні аспекти профілактики і превентивної медицини у загально-лікарській практиці. Частина І: Розділи: Профілактика анемій. Профілактика гематологічних ускладнень протипухлинної терапії. Гаптеновий агранулоцитоз. Профілактика кардіотоксичності протипухлинної терапії. Профілактичне лікування хворих на гемофілію (Бондарчук С.В., Лисенко Д.А.) Навч.посібник / за ред. Проф. Л.С. Бабінець Тернопіль: Осадца Ю.В., 2023, 616 с., 300 прим.С.525-547.; 2) Геронтологія в сімейній медицині: у 2-х ч. Частина ІІ. Розділ 19 Особливості гематологічних синдромів у людей похилого віку (Бондарчук С.В., Лисенко Д.А.) Навч.посіб./за заг.ред.проф. Л.С. Бабінець Львів: Магнолія, 2024.-478 с., 300 прим. С.157-171.].
Захищені кандидатські дисертації:
Звягіна О.В. «Анемічний синдром у хворих на анкілозивний спондиліт» (2021 р);
Сторожук О.Б. «Діагностична та прогностична значимість про- та антикоагулянтних факторів гемостазу як потенційних предикторів тромбофілій у хворих з ХХН 5Д стадії» (2021 р.)
Павлюк О.М. «Метаболічні фактори ризику порушень структурно-функціонального стану кісткової тканини у чоловіків, хворих на анкілозивний спондиліт» (2022 р.).
Нині згуртований колектив кафедри представлений як досвідченими викладачами, так і талановитою молоддю, має оптимістичний погляд у майбутнє, сповнений творчих планів і готовий виконувати складні завдання в освітній та науковій галузях медицини.
Традиції студентського наукового товариства, глибина яких сягає 60-х рр. ХХ ст., набувають у ХХІ ст. нових інноваційних обертів. На кафедрі працює студентський науковий гурток з двох дисциплін: «Внутрішня медицина» та «Професійні хвороби» (науковий куратор гуртка – ас. Бондарчук С.В.). Протягом останніх років на кафедрі внутрішньої медицини № 2 активно реалізується новий підхід у позааудиторній роботі студентів – науково-мистецькі проекти. До цих заходів залучається велика кількість студентів різних курсів. Студенти набувають досвіду колективної праці у просторі своїх груп, потоку, курсу, факультету, у співпраці з провідними науковими співробітниками музеїв та студентством інших навчальних закладів гуманітарного профілю. Тематика науково-мистецьких проектів є надзвичайно різноманітною і багатовекторною, в першу чергу пов’язаною із українською культурою та історією, постатями корифеїв вітчизняної терапевтичної науки і мистецтва водночас. Обговорюються події світової медичної науки, наукові пріоритети наших земляків, історії міжгалузевої творчої допомоги. Реалізуються художні, ораторські, пісенні, хореографічні таланти майбутніх лікарів.
Роки напруженої праці викладачів і одночасно науковців кафедри за всю її історію не проходили марно – поступово зростали покоління учнів і послідовників, які, увібравши багаторічний досвід і вміння, продовжували й продовжують славні традиції кафедри та госпітальної клініки, наслідуючи приклади своїх вчителів та примножуючи їх славу. Кафедра загалом і кожен її член сповнені сил і наснаги, готові приймати виклики нашої непростої і непередбачуваної доби, продовжувати свою багатогранну діяльність, спрямовану на підготовку висококваліфікованих медичних спеціалістів.
Кафедра госпітальної терапії (тепер внутрішньої медицини № 2) була створена в серпні 2016 р. Усі ці славетні роки поряд із першочерговим завданням – підготовкою висококваліфікованого фахівця – крокував і науковий напрям роботи.
В довоєнний період колектив кафедри працював над проблемою діагностики та лікування захворювань серцево-судинної системи та шлунково-кишкового тракту (проф. Ю.Я. Фішензон, асистенти М.Ф. Шинкарьова, С.Д. Заславська). У повоєнні роки кафедра поновлює свою наукову діяльність під керівництвом професорів – завідувачів кафедри В.О. Азлецького, Я.М. Бритвана, Б.Д. Давидова, Б.І. Лідського. У цей період наукова тематика кафедри була пов'язана з вивченням патології серцево-судинної системи та захворювань системи крові (асистенти І.А. Рибачук, В.М. Пілат, А.С. Ройзман, І.Я. Розенберг, Г.Г. Сергеєва, С.С. Мільштейн). Вийшла друком монографія Лідського Б.Й. "Практическое пособие по лекарственной терапии внутренних болезней".
За період завідування кафедрою проф. Піайдом Ф.Ф. (1952-1956 рр.) пріоритетними науковими дослідженнями були питання онкології. Під керівництвом Піайда Ф.Ф. були виконані кандидатські дисертації:
Чуберкіс Т.П. «Функциональное состояние сердечно-сосудистой системы при раке внутренних органов»
Кучеренко О.М. «Антитоксическая функция печени при раке внутренних органов».
За час завідування кафедрою проф. Колотовою Н.М. (1956-1961 рр.) наукові інтереси співробітників кафедри були пов'язані з вивченням захворювань системи крові. В результаті наукових пошуків вийшла друком монографія проф. Н.М. Колотової "Полицитемия", захищена кандидатська дисертація Войтюк В.М., надруковано 48 наукових статей. Співробітники кафедри вивчали і оволоділи методиками лікування та діагностики з використанням радіоактивних ізотопів (Кучеренко О.М., Чуберкіс Т.П.). Захищена кандидатська дисертація Головцева Ю.М. на тему «Осмотична резистентність еритроцитів при захворюваннях серцево-судинної системи» (1955 р.).
За час завідування кафедрою доц. Головцевим Ю.М. (1961-1967 рр.) на кафедрі впроваджено нові методи обстеження хворих з атеросклерозом й іншими захворюваннями серцево-судинної системи, такі як механокардіографія, полікардіографія, оксигемографія, пламенна фотометрія та інші. Наукові інтереси кафедри передовсім стосувалися вивчення екстракардіальних форм ревматизму, ревматичного пошкодження магістральних судин кінцівок, функціонального стану серцево-судинної системи при нейроциркуляторній дистонії, клінічного перебігу та лікування хронічного холециститу, ангіохоліту, хронічного гастриту, виразкової хвороби.
Захищено кандидатські дисертації:
Сокол А.Е. «Стан гемодинаміки у хворих з Аддісоновою хворобою»,
Завальнюк Н.Ф. «Біохімічні зрушення у хворих на атеросклероз під впливом йодистої терапії».
Довгаленко В.П. "Зміна харчового слиновиділення при деяких шлунково-кишкових захворюваннях" (1965 р.).
У час завідування кафедрою проф. Кучуком О.П. (1967-1991 рр.) на кафедрі виконується потужна педагогічна, наукова і лікувальна робота. Саме цей період можна назвати розквітом медичної науки і практики. Наукові інтереси кафедри в цей час були пов'язані з вивченням глютаміноаспарагінової трансамінази у хворих з гіпо- і апластичними анеміями, гострим і хронічним лейкозами, факторів згортання, природних антикоагулянтів і фібринолізу при консервації крові, функції кори наднирників і уропепсиногену у хворих на інфаркт міокарду. Клініка була забезпечена необхідними матеріалами, була створена потужна лабораторія. Тому не дивно, що за останні 5 років опубліковано 37 наукових робіт.
Захищені докторські дисертації:
Кучеренко О.М. «О происхождении, клинических проявлениях и классификации некоторых гипертонических состояниях и начальной стадии гипертонической болезни у лиц юношеского и молодого возраста» (1971 р.);
Шкляр М.Б. «Состояние гемодинамики при артериальных гипотониях различного генеза: вопросы патогенеза, клиники и лечения» (1971 р.),
Головцев Ю.М. «Матеріали до вивчення функціональних порушень печінки при атеросклерозі і патогенетичне обґрунтування деяких видів його лікування» (1971 р.).
Захищені кандидатські дисертації:
Жук Н.С. «Показатели свертывающей и антисвертывающей систем крови у больных деструктивными формами туберкулеза при операциях на легких»;
Новицький Г.А. «Лечение больных инфекционным неспецифическим полиартритом углекисло-радоновыми водами с пониженным содержанием дейтерия на курорте «Хмельник»;
Проценко Л.Ф. «О патогенезе анемии при диффузном нефрите у детей»;
Виктора В.А. «Особенности течения беременности, родов и послеродового периода у женщин, страдающих ревматическими пороками сердца».
Чернобровий В. М. «Радиотелеметрические показатели функционального состояния желудка у больных язвенной болезнью и хроническим гастритом» (1970 р.);
Яковлева О. О. «Коморбідні зв’язки бронхо-легеневих захворювань з порушеннями шлунку» (1974 р.);
Черешнюк Л. В. «Функціональний стан міокарда у хворих з запальними захворюваннями піднебінних мигдаликів» (1980 р.);
Шанчук О. Г. «Заболевания органов дыхания у рабочих производства синтетических моющих средств» (1986 р.).
У 1971 р. під загальною редакцією М.Б. Шкляра перевиданий підручник "Діагностика внутрішніх хвороб" Бориса Соломоновича Шкляра, який був доповнений новими розділами.
Надруковані методичні матеріали: "Методические указания для студентов VI курса к практическим занятиям по неотложной помощи и интенсивной терапии при некоторых ургентных состояниях в клинике внутренних болезней", "Пути совершенствования клинического мышления в интернатуре по терапии", "Работа врачей-интернов терапевтического профиля в поликлинике", "Методика расшифровки ЭКГ", "Дифференциальная диагностика бронхообструктивного синдрома", „Техника и методика усовершенствования внутриполостной рН-метрии верхнего отдела желудочно-кишечного тракта", "Клиническое применение индикатора кислотности желудка" (В.М. Чернобровий, Н.А. Півторак), "Способы диагностики метаболической функции легких и возможности ее коррекции" (О.О. Яковлева),
Захищено три докторські дисертації:
Маленький В.П.: "Епідеміологія, клініка, діагностика, лікування і профілактика хронічного бронхіту у механізаторів сільського господарства" (1989 р.);
Чернобровий В.М.: "Шляхи поліпшення діагностики і лікування виразкової хвороби і хронічного гастриту (досягнення та перспективи внутрішньо-шлункової рН-метрії" (1989 р.);
Яковлєва О.О.: "Диференційна діагностика ліпідного гемостазу у хворих неспецифічними захворюваннями легенів та обгрунтування метаболічної корекції вітамінами А та В" (1991 р.).
За період з 1981 по 1990 рр. співробітниками кафедри опубліковано 48 наукових робіт. Пріоритетними стали дослідження порушення функцій сурфактантної системи легень, складу конденсату видихуваного повітря (що стало мотивом для розуміння видільної функції легень), вторинних дисліпідемій, поглибленого вивчення наслідків оксидативного стресу, його впливи на фосфоліпідний склад мембран, забезпеченість токоферолом у хворих з гострими та хронічними обструктивними захворюваннями легень.
Кафедра у період незалежної України
З 1992 по 2008 рр. кафедру очолював проф. В.П. Маленький. Основними напрямками наукових досліджень співробітників кафедри, як і раніше, є проблеми пульмонології, гастроентерології і професійних захворювань. Зокрема, виконуються дві науково-дослідні роботи кафедри, проводяться пошуки зі застосування ентеросорбента полісорбу при лікуванні хворих гострими та хронічними запальними процесами бронхо-легеневої системи і органів травлення. За результатами наукових досліджень лише за три роки опубліковано 56 праць, проведена І-ша Подільська науково-практична конференція гастроентерологів. На кафедрі здійснюється клінічна оцінка нової медичної техніки для спелео- та фітотерапії, впроваджено фібробронхоендоскопічне обстеження хворих.
Захищено кандидатські дисертації:
Півторак Н. А. "Критерії доклінічної діагностики і особливості амбулаторного лікування загострень виразкової хвороби дванадцятипалої кишки" (1993 р.);
Масік Н.П. «Ефективність комбінованої еферентної та медикаментозної терапії у хворих на хронічні обструктивні захворювання легенів» (1998 р.);
Шанчук О.М. «Клінічний перебіг хронічного гнійного бронхіту при комплексному лікуванні з використанням ендобронхіальних санацій розчином декаметоксину» (1998 р.);
Корнєєв Б.І. «Особливості діагностики та фармакотерапії хронічного безкам’яного холециститу у зв’язку з порушеннями функціонально-морфологічного стану слизової оболонки шлунка» (1998 р.).
У новому тисячолітті (ХХІ ст.) творча енергія співробітників кафедри спрямована на активну співпрацю з деякими науково-дослідними інститутами АМН України, зокрема з інститутом гематології та трансфузіології, інститутом геронтології. Основними напрямками наукових досліджень співробітників кафедри, як і раніше, є проблеми пульмонології, а також гематології, вертебрології.
11 квітня 2000 року проведено всеукраїнську науково-практичну конференцію «Невідкладні стани в медицині», яка присвячувалась ювілею МКЛ №2 м. Вінниці.
Захищено кандидатські дисертації:
Нечипорук С. В. «Корекція стану кардіореспіраторної системи методом гіпокситерапії у хворих на хронічний обструктивний бронхіт» (2001 р.);
Лисенко Д.А. «Клініко-імунологічний моніторинг хворих на хронічну мієлоїдну лейкемію на фоні хіміотерапії та імунокорекції» (2002 р.);
Черноброва О.І. «Особливості перебігу та лікування анемії, що зумовлена комбінацією дефіциту заліза і вітаміну В12» (2007 р.);
Коробко О. А. «Оптимізація лікування хворих на бронхіальну астму середньої тяжкості із застосуванням акустичного вібромасажу легень» (2009 р.);
Ільюк І. А. «Ефективність тіотриазоліну в комплексному лікуванні хворих на негоспітальну пневмонію з проявами ендогенної інтоксикації» (2009 р.).
Захищено докторські дисертації:
Колісник П.Ф. «Патологія хребта як ланка патогенезу захворювань внутрішніх органів та фактор їх резистентності до лікування» (2002 р.);
Солєйко О.В. «Хронічна постінфарктна аневризма серця: аспекти патогенезу, діагностики та лікування» (2008 р.).
Видано навчальні посібники: 1) Професійні хвороби. За редакцією В.П. Маленького (2005 р.); 2) Невідкладні стани в медицині (2000 р.); 3) В.П. Маленький. Терапія в тестах. (2002 р.); 4) Лекції з гематології / П.М. Перехрестенко, Л.М. Ісакова, Н.М. Третяк, Д.А. Лисенко, С.В. Бондарчук (2005 р.); 5) Госпітальна терапія (посібник для самостійної підготовки до практичних занять) / В.П. Маленький, Н.П. Масік (2005 р.).
Під керівництвом проф. Колісника П.Ф. (2008-2013 рр.) співробітниками кафедри виконані науково-дослідні роботи «Особливості лікувально-реабілітаційних заходів при захворюваннях внутрішніх органів і систем у пацієнтів з супутньою патологією хребта», «Розробка програм багаторівневої медичної реабілітації при захворюваннях внутрішніх органів та систем».
В рамках НДР надруковано 157 наукових робіт, видано 2 методичних рекомендації, 3 підручники, 2 монографії, 17 раціональних пропозицій, отримано 22 патенти, створено пристрої: 1) для проведення лікувальної гімнастики в тракційно-тренуючому режимі, 2) електронний вимірювач станової сили людини (пристрій для моделювання нейрона), 3) пристрій для лікування хворих з вертебральною патологією грудного і поперекового відділу хребта. Видані підручники: 1) Павлов С.В., Кожем’яко В.П., Колісник П.Ф., Василенко В.Б., Козловські Т.І., Думенко В.П. Фізичні основи біомедичної оптики (2010); 2) Павлов С.В., Тимчик Г.С., Кожемяко В.П., Готра З.Ю., Колісник П.Ф., Козловська Т.І. Оптико-електронні медичні системи (2011); 3) Лисенко Д.А. Онкогематологія (розділ у посібнику) / Клінічна онкологія: посіб. для студ. ВМНЗ IV рівня акредитації та лікарів-інтернів: присвяч. 200-річчю з дня народж. видатного вчен. М. І. Пирогова / Б.А. Болюх [та ін.]; ред. Б.А. Болюх. (2012); 4) Фотоплетизмографічні технології контролю серцево-судинної системи / Колісник П.Ф. (2012).
Було захищено кандидатські дисертації:
Хомовський В.В. «Вертеброгенні предиктори артеріальної гіпертензії, диференційно-діагностичні критерії та особливості лікування» (2007 р.);
Гуменюк І. П. „Особливості клінічного перебігу, діагностики та лікування хронічного обструктивного захворювання легень при супутній патології хребта” (2010 р.);
Кравець Р. А. «Особливості перебігу, діагностики та лікування кардіалгій та аритмій серця при дорсопатіях та остеопорозі хребта» (2010 р.);
Березюк О. М. «Значення еритропоетину в розвитку анемічного синдрому при гострій мієлоїдній лейкемії» (2011 р.);
Осипенко І. П. «Маркери дисплазії сполучної тканини у хворих з ідіопатичним пролабуванням мітрального клапану та принципи колагенонормалізуючої терапії» (2013 р.).
З вересня 2013 року посаду завідувача кафедри займає д. мед. н., професор Шевчук С. В. Провідний напрям наукової діяльності кафедри – дослідження та вирішення проблем сучасної ревматології. За останнє десятиріччя колективом кафедри було надруковано 230 статей у фахових журналах, 217 тез у матеріалах як науково-практичних конференцій, так і конгресів світового рівня; видано 1 підручник, 2 монографії, 5 навчальних посібників, зокрема, «Сучасні підходи до реабілітації інвалідів працездатного віку внаслідок хвороб органів дихання» (Шевчук В.І., Забур’янова В.Ю., Вернигородська М.В., Шевчук С.В., Ільюк І.А., Коробко О.А., 2014 р.), «Синдром недиференційованої дисплазії сполучної тканини: від концепції патогенезу до стратегії лікування» (Солєйко О.В., Рикало Н.А., Осипенко І.П., Солейко Л.П., 2014 р.), 3 методичних рекомендації (2012-2013 рр.), 19 інформаційних листів, 37 патентів на винаходи та корисні моделі.
З 2013 р. кафедра є базою Фармакологічного комітету України з випробувань нових лікарських препаратів, приймає участь в проведенні міжнародних рандомізованих контрольованих клінічних досліджень, співпрацює з іншими науковими закладами – Інститутом кардіології ім. М.Д. Стражеска, НДІ геронтології імені Д.Ф. Чеботарьова НАМН України, Українським НДІ реабілітації інвалідів та іншими кафедрами університету. На кафедрі виконувались науково-дослідні роботи «Вивчення закономірностей формування серцево-судинних уражень у хворих на антифосфоліпідний синдром та розробити диференційовані підходи до їх фармакологічної корекції», «Вивчити роль клінічних, молекулярно-генетичних, метаболічних, імунозапальних та гемокоагуляційних чинників у формуванні серцево-судинних уражень при ревматоїдному артриті та розробити рекомендації з їх профілактики та лікування», «Вивчити клінічні, метаболічні, генетичні та імунозапальні чинники розвитку остеопорозу та саркопенії у хворих на системний червоний вовчак та розробити підходи до їх фармакологічної корекції».
Захищена докторська дисертація Масік Н. П. «Системні порушення метаболізму кісткової тканини у хворих різних вікових груп з хронічними захворюваннями органів дихання та шляхи їх корекції (клініко-експериментальне дослідження)» (2014 р.).
Захищено кандидатські дисертації:
Куриленко І.В. «Анемічний синдром у хворих на системний червоний вовчак» (2013 р.);
Сегеда Ю.С. «Фактори ризику атеросклеротичного ураження судин у хворих на антифосфоліпідний синдром» (2015 р.);
Черних М.О. «Ішемічна хвороба серця на тлі недиференційованої дисплазії сполучної тканини: особливості перебігу, аспекти діагностики та прогнозу» (2016 р.).
З кінця 2019 р. весь світ і Україна боролися з пандемією COVID-19, а з лютого 2022 р. – з повномасштабним вторгненням росії. Не дивлячись на неймовірні випробування, які випали на долю українців, співробітники кафедри продовжують наукові дослідження, виконуючи НДР «Генетичні та середовищні чинники ризику розвитку остеопорозу та його ускладнень у хворих на ревматичні захворювання». Опубліковано 67 статей у наукових медичних виданнях України та зарубіжжя, 31 статей у науко-метричних базах Scopus та Web of Science, 40 тез, 9 патентів на винаходи і корисні моделі, 5 нововведень, 2 монографії [1) Вторинний остеопороз За ред. Поворознюка В.В., Григор’євої Н.В., Дедух Н.В. Кропивницький. Поліум, 2021.-528 с., Тираж 100 пр. (Масік Н.П. 14 розділ, С.439-469.), 2) Liudmyla Denyshchych, Sergii Shevchuk Advances in Health and Disease. Volume 75 Published by Nova Science Publishers, Inc., New York, USA, 2023, pp. 233. ISBN: 979-8-89113-189-7.] і 2 посібники [1) Актуальні аспекти профілактики і превентивної медицини у загально-лікарській практиці. Частина І: Розділи: Профілактика анемій. Профілактика гематологічних ускладнень протипухлинної терапії. Гаптеновий агранулоцитоз. Профілактика кардіотоксичності протипухлинної терапії. Профілактичне лікування хворих на гемофілію (Бондарчук С.В., Лисенко Д.А.) Навч.посібник / за ред. Проф. Л.С. Бабінець Тернопіль: Осадца Ю.В., 2023, 616 с., 300 прим.С.525-547.; 2) Геронтологія в сімейній медицині: у 2-х ч. Частина ІІ. Розділ 19 Особливості гематологічних синдромів у людей похилого віку (Бондарчук С.В., Лисенко Д.А.) Навч.посіб./за заг.ред.проф. Л.С. Бабінець Львів: Магнолія, 2024.-478 с., 300 прим. С.157-171.].
Захищені кандидатські дисертації:
Звягіна О.В. «Анемічний синдром у хворих на анкілозивний спондиліт» (2021 р);
Павлюк О.М. «Метаболічні фактори ризику порушень структурно-функціонального стану кісткової тканини у чоловіків, хворих на анкілозивний спондиліт» (2022 р.).
Нині згуртований колектив кафедри представлений як досвідченими викладачами, так і талановитою молоддю, має оптимістичний погляд у майбутнє, сповнений творчих планів і готовий виконувати складні завдання в освітній та науковій галузях медицини.
Традиції студентського наукового товариства, глибина яких сягає 60-х рр. ХХ ст., набувають у ХХІ ст. нових інноваційних обертів. На кафедрі працює студентський науковий гурток з двох дисциплін: «Внутрішня медицина» та «Професійні хвороби» (науковий куратор гуртка – ас. Бондарчук С.В.). Протягом останніх років на кафедрі внутрішньої медицини № 2 активно реалізується новий підхід у позааудиторній роботі студентів – науково-мистецькі проекти. До цих заходів залучається велика кількість студентів різних курсів. Студенти набувають досвіду колективної праці у просторі своїх груп, потоку, курсу, факультету, у співпраці з провідними науковими співробітниками музеїв та студентством інших навчальних закладів гуманітарного профілю. Тематика науково-мистецьких проектів є надзвичайно різноманітною і багатовекторною, в першу чергу пов’язаною із українською культурою та історією, постатями корифеїв вітчизняної терапевтичної науки і мистецтва водночас. Обговорюються події світової медичної науки, наукові пріоритети наших земляків, історії міжгалузевої творчої допомоги. Реалізуються художні, ораторські, пісенні, хореографічні таланти майбутніх лікарів.
Роки напруженої праці викладачів і одночасно науковців кафедри за всю її історію не проходили марно – поступово зростали покоління учнів і послідовників, які, увібравши багаторічний досвід і вміння, продовжували й продовжують славні традиції кафедри та госпітальної клініки, наслідуючи приклади своїх вчителів та примножуючи їх славу. Кафедра загалом і кожен її член сповнені сил і наснаги, готові приймати виклики нашої непростої і непередбачуваної доби, продовжувати свою багатогранну діяльність, спрямовану на підготовку висококваліфікованих медичних спеціалістів.
Література, що видана кафедрою
- Невідкладні стани в медицині (за матеріалами науково-практичної конференції, присвяченої 85-річчю 2-ої міської клінічної лікарні м. Вінниці). Редактор – В.П. Маленький. Вінниця – 2000. – 354 с.
- В.П. Маленький. Терапія в тестах. Навчальний посібник. В.: ТВП «Книга-Вега» ВАТ «Віноблдрукарня», – 2002. – 312 с.
- За редакцією В.П. Маленького. Професійні хвороби. – Вінниця: НОВА КНИГА, 2005. – 336 с.: іл.
- Лекції з гематології / П.М. Перехрестенко, Л.М. Ісакова, Н.М. Третяк, Д.А. Лисенко, С.В. Бондарчук. – К.: Нора-прінт, 2005. – 128 с.
- Маленький В.П., Шевчук С.В., Масік Н.П., Нечипорук С.В., Забур'янова В.Ю., Коробко О.А., Ільюк І.А., Данченко О.П. Принцип реабілітації хворих на бронхіальну астму та хронічні обструктивні захворювання легенів (методичні рекомендації). - Вінниця, 2012. - 32 с.
- Клінічна онкологія [Текст]: Посібник для студентів вищих медичних навчальних закладів ІV рівня акредитації та лікарів інтернів / Б.А. Болюх, В.В. Петрушенко, А.А. Ткач, Д.А. Лисенко та інш.; за редакцією д.м.н., проф. Б.А. Болюха. – Вінниця: ДП «ДКФ». – 2012. – 704 с.
- Шевчук С.В., Куриленко І.В. Диференційна діагностика та особливості лікування анемічного синдрому у хворих на системний червоний вовчак (методичні рекомендації). - Вінниця, 2013. - 44 с.
- Шевчук С.В., Сегеда Ю.С. Сучасні принципи діагностики та лікування дисліпідемії у хворих на антифосфоліпідний синдром (методичні рекомендації). - Вінниця, 2013. - 52 с.
- Шевчук В. І., Забур’янова В. Ю., Вернигородська М. В., Шевчук С.В., Ільюк І.А., Коробко О.А. Сучасні підходи до реабілітації інвалідів працездатного віку внаслідок хвороб органів дихання: (посібник). - Вінниця, 2014. - 64 с.
- Солєйко О.В., Рикало Н.А., Осипенко І.П., Солейко Л.П. Синдром недиференційованої дисплазії сполучної тканини: від концепції патогенезу до стратегії лікування (навчальний посібник для студ. вищих мед. навч. закладів ІІІ-ІV рівнів акред.). - Вінниця: Нова Книга, 2014. - 168 с.
- Масік Н.П. Обличчя кафедри госпітальної терапії. Історичний нарис до 80-річчя створення кафедри. - Вінниця: ВНМУ, 2019. - 80 с.
- Поворознюк В.В., Григор’єва Н.В., Дедух Н.В. Вторинний остеопороз. - Кропивницький. Поліум, 2021.-528 с. (Масік Н.П. 14 розділ, С.439-469.)
- Denyshchych, L., & Shevchuk, S. (2023). Bone Turnover Markers and Their Role in Osteoporosis, Particularly in Patients with Rheumatic Diseases. In L. T. Duncan (Ed.), Advances in Health and Disease (Vol. 75). Nova Science Publishers. ISBN: 979-8-89113-189-7.
Контакти
Кафедра внутрішньої медицини № 2 розташована на базах Університетської лікарні ВНМУ ім. М.І. Пирогова за адресою вул. Хмельницьке шосе, 104, проспект Коцюбинського, 6.
Практичні заняття зі студентами також проводяться на базах МКЛ ШМД (вул. Київська 68), МКЛ № 1 (Хмельницьке шосе, 98), ВОКЛ ім. М.І. Пирогова (вул. Пирогова, 46), Військо-медичного клінічного центру Центрального регіону (вул. Князів Коріативичів, 185).
Наша електронна адреса: intmed2@vnmu.edu.ua
